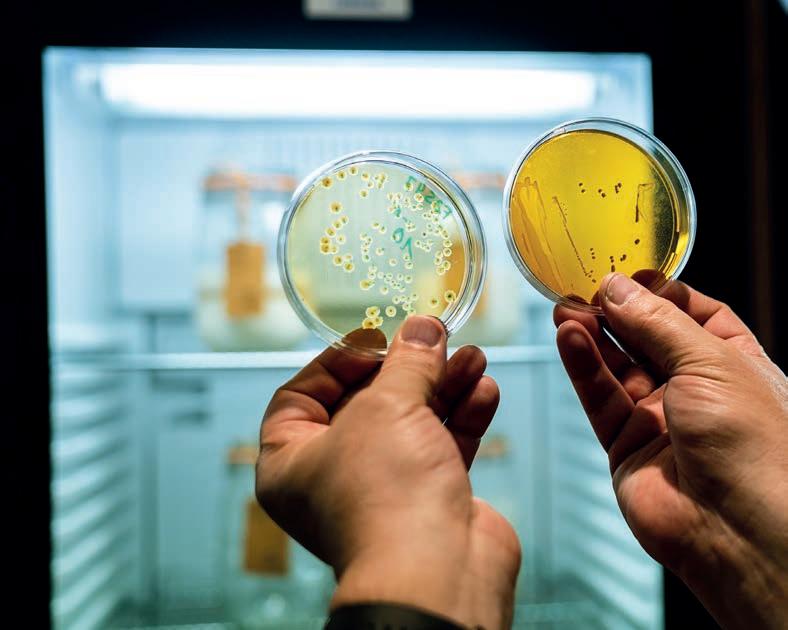

Korona Tatr to aż 60 szczytów do zdo bycia. Zatem każdy, kto kocha górskie wędrówki, przez większość roku ma co robić. I do końca swo ich dni będzie odkrywał jakąś górę, na której nie postała jeszcze jego noga. Naturalny rytm przy rody, warunki atmosferyczne, zmiany zachodzące w ciągu lat sprawią, że konkretny szczyt będzie zachwycać wciąż innym widokiem. Zawsze będzie coś do odkrycia.
Dokładnie tak samo wygląda to w piekarni czy cu kierni. Bo i mąka, i cukier są przecież składnikami pochodzącymi z przyrody. Goszczący na naszej okładce wyjątkowy bibliotekarz, który kolekcjonu je zakwasy, Karl de Smedt przekonuje, że właśnie dlatego trzeba w znacznie głębszy sposób podejść do pieczenia chleba czy ciast. Badać produkt ba zowy, czyli zakwas, tak jak on to robi. W swoim centrum badawczym porównuje zakwasy pochodzące z różnych szerokości geograficznych, wskazując, że ich bogactwo opiera się właśnie na tym, z jakiej gle by pochodziło ziarno mąki użyte w ich produkcji. I jak prawdziwy podróżnik odwiedza kolejne wyjątkowe piekarnie, stwierdzając, że najlepszego chleba nie ma. Są tylko kolejne ciekawe bochenki do odkrycia.
Postawa odkrywcy zawsze czyni nas też zdobywcami. Ciekawość prowadzi do podążania jeszcze nieprze tartymi szlakami, a to sprawia, że możemy być pierwszymi, którzy doszli do pewnego punktu. Zdobywamy wiedzę, doświadczenie, pewność siebie, a także – jak jeden z naszych rozmówców, Master Baker 2022 Paweł Tkaczuk – miejsce na podium konkursów i mistrzostw. Podobnie Igor Zaritskiy, który otrzymał przepustkę do top finału World Chocolate Masters, jako pierwszy pastry chef narodowości ukraińskiej.

Zdobywanie szczytów, odkrywanie nowych miejsc czyni nas nie tylko mistrzami fachu, ale po prostu szczę śliwymi ludźmi. Ludźmi, którzy potrafią z pasją ruszyć w podróż po fascynującym świecie mąki, cukru, zakwasu, śmietany, jajka i całej galaktyki innych produktów.
Redakcja Mistrza Branży






















Redakcja i Marketing
ul. Klimczoka 9, 40-857 Katowice redakcja@MistrzBranzy.pl marketing@MistrzBranzy.pl
Natalia Aurora Ignacek P.O. Redaktor Naczelnej aurora@MistrzBranzy.pl +48 605 628 326
Beata Sitarz Menadżer Produktu sitarz@MistrzBranzy.pl +48 881 610 668
Agnieszka Mrukowicz Menadżer Produktu mrukowicz@MistrzBranzy.pl + 48 881 610 669
Wydawnictwo Grupa 69
ul. Klimczoka 9 40-857 Katowice
Redaktor Techniczny Przemysław Ścierski p.scierski@MistrzBranzy.pl + 48 881 44 00 88
Dział Prenumeraty i Kolportażu prenumerata@MistrzBranzy.pl +48 881 610 660
Korekta Iwona Guzik DTP Patrycja Krzemień
Zdjęcie na okładkę Puratos konto bankowe 27 1140 2004 0000 3502 8222 7728

www. MistrzBranzy.pl
Wszelkie prawa zastrzeżone. Żaden z utworów zawartych w czasopiśmie (w całości ani w części) nie może być bez pisemnej zgody Wydawcy wykorzystany lub użyty na jakimkolwiek polu eksploatacji, w tym nie może być w jakikolwiek sposób powielany ani rozpowszechniany (w tym w formie elektronicznej, przez digitalizację, publikacje i rozpowszechnianie w Internecie). Wykorzystanie utworów bez zgody podlega odpowiedzialności prawnej. Redakcja nie ponosi odpowiedzialności za treść reklam ogłoszeń. Redakcja nie zwraca materiałów niezamówionych oraz zastrzega sobie prawo do skracania i adiustacji tych tekstów oraz zmiany ich tytułów. Wszelkie znaki firmowe towarowe oraz zrzuty ekranowe są zastrzeżone przez ich właścicieli i zostały użyte wyłącznie w celach informacyjnych. W czasopiśmie wykorzystano zdjęcia przesłane przez autorów oraz z serwisów: 123RF, iStockphoto, Stock.XCHNG
taki bibliotekarz – rozmowa z Karlem de Smedtem
 Portal i poradnik drukowany
Portal i poradnik drukowany



Zakwas porównuje do dziecka, zwierzątka albo miasta. W swojej bibliotece hoduje ich aż 147 i doskonale zna każdy. Czy któryś uważa za szczególnie ważny? Czym wyróżnia się doskonały zakwas? I dlaczego miłośnik chleba na zakwasie nie znosi słowa zakwas? O miłości do chleba opowiada jedyny na świecie bibliotekarz zakwasów Karl de Smedt.


Natalia Aurora Ignacek: Człowiek sły szy Twoje nazwisko i momentalnie ma przed oczyma świeży bochenek chle ba. Na całym świecie jesteś kojarzony z piekarstwem i zakwasem, ale zdaje się, że nie zawsze tak było. Wcześniej pracowałeś jako cukiernik! Co spo wodowało, że ostatecznie wybrałeś chleb, a nie ciastka?


Karl: To długa historia… Już gdy miałem 10-11 lat, wiedziałem, że chcę być w przy szłości pastry chefem. Dlatego w wieku 12 lat poszedłem do szkoły ukierunkowa nej właśnie na cukiernictwo (tak, mamy w Belgii taką opcję już na wczesnym etapie edukacji). Po ukończeniu szkoły przez 6 lat

pracowałem w Brukseli jako pastry chef. Wyjątkiem były weekendy, kiedy chodzi łem pomagać do pewnej piekarni, robiąc bułki, bagietki i tego typu rzeczy. Jednak nawet w 1994 r., gdy zdecydowałem się dołączyć do ekipy Puratos, nadal starałem się o stanowisko cukiernicze. Całe szczęście nie było wolnego etatu (śmiech).
Szukali kogoś od chleba?
Tak, testera do laboratorium chleba. Zdecy dowałem się. I tak właśnie upiekłem swój pierwszy chleb na zakwasie. To było nie samowite przeżycie! Okazało się, że można zrobić chleb z mąki i wody, nikt wcześniej mi tego nie pokazał! Byłem w szoku. Znów poczułem się jak uczeń, który chce poznać, zrozumieć. Dlatego nawet gdy zrobiło się miejsce na stanowisko cukiernicze, już wiedziałem, co chcę robić przez następne lata.

Nie korciło Cię, by otworzyć własną piekarnię?
Cóż, zostałem technologiem piekarstwa, pokochałem pieczenie chleba, ale stało się coś paradoksalnego. W 2002 r., po tym jak nie potrafiłem pozbyć się kataru, poczucia zimna i guli w gardle, okazało się, że mam uczulenie na… mąkę! Konkretnie na mąkę żytnią. Pierwsze zalecenie mojego lekarza brzmiało, że mam przestać zajmować się w pracy tym, co robiłem dotychczas (śmiech). Na szczęście nie oznaczało to odejścia z pracy. Zacząłem więc organizować szkolenia, które polegały
Rozmawiała: Natalia Aurora Ignacekna wyjaśnianiu nauki stojącej za technologią produkcji chleba i zakwasu, działania enzy mów. W firmie miałem nowoczesne laboratorium i sprzęty do zgłębiania tej wiedzy. Moim zadaniem było przełożyć to na prosty język dla piekarzy.

I tak narodził się pomysł na Bibliotekę Zakwasów?
Jeszcze nie. Najpierw w 2008 r. postano wiliśmy otworzyć z firmą Puratos Centrum Smaku Chleba (Centre for Bread Flavour). Pomysł na bibliotekę zaczął kiełkować w 2009 r. Miałem właściwie gotową wizję, musiałem tylko przekonać do niej firmę. Problem polegał na tym, że nikt właściwie nie rozumiał, co to miało być (śmiech). Gdy w 2012 r. udało mi się o tym porozmawiać bezpośrednio z właścicielem firmy, zapytał tylko, ile czasu potrzebuję. Rok później bi blioteka już funkcjonowała.
Co jest takiego fascynującego w zakwasie, że poświęciłeś mu centrum badawcze, jakim jest Biblioteka Za kwasów?
To ciągłe odkrywanie bioróżnorodności, a także zależności między różnymi czynnikami, które wpływają na zakwas. Okazuje się, że nie znamy drugiego takiego składni ka, który był z nami przez tysiące lat. Ja nie mam nic przeciwko drożdżom, ale każdy, kto choć raz spróbuje chleba na zakwa-
sie, poczuje różnicę. Ten chleb będzie nie tylko smaczniejszy, ale bardziej interesu jący. Zaczniesz się zastanawiać, dlaczego ma więcej smaku, zapachu, dlaczego nie czujesz się ociężały po zjedzeniu. Przez ostatnie 10 lat chleb miał na świecie złą passę właśnie dlatego, że zapomnieliśmy o pieczywie na zakwasie. A ja mam potrzebę mówić o t ym głośno – chleb jest dobry!
Masz niezłą misję do wykonania! Tworzenie chleba na zakwasie to nie tylko wiedza technologiczna, rozumienie procesów. Pieczenie bochenków ma też stronę emocjonalną, z zakwasem trzeba bowiem postępować prawie jak z dzieckiem (śmiech). Musisz o niego dbać, opiekować się, dokar miać. Jednak dbasz o coś, co potem odwdzięczy ci się w niesamowity sposób. To nie jest
Im starszy zakwas tym lepszy? Dla Bibliotekarza Zakwasów liczy się nie tyle metryka zakwasu, co jego bioróżnorodnośc. A ta zależy od położenia geograficznego, rodzaju gleby i wielu innych zmiennych, które wpłynęły na jakosć ziarna, a potem i mąki, która była użyta do stworzenia zakwasu
zamiennik kota lub psa, to coś znacznie wię cej niż produkt, surowiec kulinarny. Powstaje emocjonalna więź. Finalnie kładziesz chleb na stole i wywołujesz dobre emocje wśród ludzi. Dlaczego właściwie ludzie zapomnieli o zakwasie?

Bo stali się wygodni. Dawniej, gdy nie było lodówek ani w ogóle nowoczesnych
technologii, piekarze musieli wstawać do zakwasu co 3-4 godziny. To była ich co dzienność. Naukowcy szukali wyjścia z tej sytuacji, chcieli, by wypiek stał się łatwiejszy. I tak oto Francuz Louis Pasteur napi sał w XIX w. rozprawę o różnego rodzaju fermentacjach. Wyjaśnił, jak wyizolować i hodować drożdże. To był krok milowy w dziejach, także w historii chleba. Opisał, jak to wykorzystać w komercyjnej pro dukcji chleba. Skutki tego wszyscy znamy i odczuwamy do dziś.
Na salonach zagościły drożdże… Pierwszą fabrykę drożdży otwarto w Eu ropie w 1879 r., wkrótce powstała taka w USA. I nagle tak po prostu piekarze mieli dostęp do składnika, który sprawiał, że mogli produkować łatwiej, szybciej i na większą skalę. To był największy przełom w piekarstwie, ale też… katastrofa. Final nie bowiem sprawiło to, że chleb stał się tańszy, produkowano go na masową skalę, ale był też coraz mniej wartościowy…
Chyba zaczynamy to zrozumieć. Z tego, co obserwuję, zarówno w Polsce, jak i innych krajach panuje boom na chleba na zakwasie.

Cóż, w historii zawsze to tak wygląda, jest jak w modzie. Po latach „udoskona leń” i eksperymentów zerkamy, jak to było robione na początku. Na szczęście żyje-
my w takich czasach, że mamy narzędzia i technologie, które sprawiają, że teraz i kiedyś mogą się szczęśliwie spotkać. Ta wiedza i tradycja mogą wreszcie współpracować. I to właśnie staramy się robić w f irmie Puratos. Fermentacja to temat rzeka! Zobacz, ile jest produktów opar tych na fermentacji: piwo, wino, ser, pieprz. W wielu z t ych dziedzin mamy mistrzów fermentacji, np. piwowarów. Winemaker przez 3 lata studiuje mikrobiologię, zanim przystąpi do swojego fachu. Ma stopień magistra w rolnictwie i ukończone specjalistyczne studia tylko po to, by raz do roku zebrać owoc i zrobić z niego najlepsze wino. Tak samo powinno być w piekarstwie. W końcu cóż ważniejszego od chleba jest w codziennym menu?
Mam do Ciebie jedno istotne, choć może kontrowersyjne pytanie: czy to prawda, że im starszy zakwas, tym lepszy?
Ooo, wkraczamy na bardzo grząski grunt! Nie wiem! Żaden zakwas nie ma aktu uro dzenia. Mam w bibliotece 137-letni zakwas, choć musisz mi uwierzyć na słowo, bo nie mam na to papierów. W teorii jest tak, że zakwas jest tak stary, jak jego poprzednie karmienie. Ciągle jest więc czymś innym, bo mikroorganizmy bez przerwy w nim dojrzewają i umierają. Osobiście patrzę na zakwas jak na miasto. Miasto, które
istnieje od wielu setek lat, ma sil ną populację, solidne mury obron ne, jest dobrze chronione i bogate. W przeciwieństwie do młodego miasta, które łatwo przejąć, poko nać. Stary zakwas trudniej zmienić. Ale czy jeden jest lepszy od dru giego? Niekoniecznie, ja tak tego nie widzę.
W wielu moich kilkudziesięciolet nich zakwasach bioróżnorodność jest znacznie wyższa niż w młodych zakwasach. W tych starych są obecne 3 rodzaje drożdży i 6 rodzajów bakterii kwasu mlekowego, a w młodym mam tylko 1 szczep tego i tego. Dlacze go tak jest? Niestety współcześnie używanych jest mnóstwo pestycydów, które mają „chronić” rośliny, glebę. I dlatego ta różnorodność jest taka uboga. Dlatego sta ry zakwas jest świetny, nie ze względu na swój „wiek”, a z racji na to, że ówczesna mąka pochodziła z lepszej jakości gleby.
Podobno to właśnie w Almaturze w starożytności wytwarzano najlepszy chleb. Był to oczywiście chleb na zakwasie z pszenicy durum...
próbować. Miałem czas, w końcu świat się zatrzymał! Zacząłem więc robić cynamonki, ptysie, ciasteczka, donuty, muffiny. Ku mo jemu zaskoczeniu wszystko działało. Ciasto francuskie z zakwasem? To było prawdziwy szok! Nigdy wcześniej nie pomyślałbym, że to może się udać. A jednak! Efekt był tak imponujący, że pokazywałem to nawet u Paula Bocuse na szkoleniu. Dziś uważam, że fermentacje powinny być ważną częścią cukiernictwa. To wielka rewolucja, która dopiero nadchodzi.
Włoch, które jest jednym z naj starszych. Podobno to właśnie tam w starożytności w imperium rzymskim wytwarzano najlepszy chleb. Był to oczywiście chleb na zakwasie z pszenicy durum. Z kolei w Meksyku jadłem birote. To chleb na zakwasie, który jest odświeżany co tydzień. Zamiast wody i mąki co tydzień dodaje się do niego sok z li monki, piwo i jajka. Piecze się go w piecu kamiennym, wychodzi bardzo chrupiąca skórka. Jednak najbardziej zadziwiający chleb jadłem w Turcji w miasteczku Gümüşhane w górach nie daleko Morza Czarnego. Bochenki były po części ze zwykłej pszenicy, po części z pszenicy durum, miały po 3-4 kilogramy i były pieczone po kilka godzin w piecu opalanym drewnem.
Odkryłeś już tajemnicę idealnego chleba?
Mam jeszcze kolejną problematyczną kwestię do poruszenia. Zakwas koja rzony jest niemal wyłącznie z chlebem, a przecież jego właściwości (tak jak drożdży) mogą z powodze niem być wykorzystywane w cukier nictwie, prawda?
Absolutnie! W 2018 r. pojechałem na zachodnie wybrzeże Alaski, gdzie również jest miejsce dedykowane zakwasowi. Opowiada się tam historię o poszukiwaczach złota, którzy wędrowali w zimnie i śniegu, a je dyne, co mieli, to zakwas, który musieli chronić własnym ciałem. I kilka kilogramów mąki. Gdy się zatrzymywali, robili pancakes na zakwasie. I to mnie bardzo zaintereso wało. Podążając tym tropem, udało mi się spotkać z prapraprawnukami tych ludzi, jedna z tych osób pokazała mi, jak robić gofry. Jako Belgowie najlepiej na świecie wiemy, jak robić gofry, ale te gofry… były zdumiewające! Nigdy nie jadłem lepszych, a zawierały tylko proste składniki i zakwas. Tak oto zaczęło się moje wzmożone zain teresowanie zakwasem w cukiernictwie.
Mimo wszystko to chyba dopiero początek pewnego zwrotu… Vanessa Kimbell, jedna z naszych amba sadorek, w czasie pandemii zadzwoniła do mnie z informacją, że pisze książkę o wyko rzystaniu zakwasu w słodkich wypiekach. Przy okazji zapytała, czy chciałbym je wy-
Mimo że w wielu krajach zakwas był znany i używany od setek lat… Wszędzie tam, gdzie ludzie nie zapomnieli o mące żytniej, tam od zawsze mocno kultywowana jest tradycja pieczenia chle ba na zakwasie. W Słowenii, Polsce, Au strii, Skandynawii – w tych krajach nigdy nie zanikła. Dla wielu ludzi taki chleb jest zbyt kwaśny, wytrawny. Dlatego piekarze starali się wymyślić, jak sprawić, by był mniej kwaśny.
Dziś wiedza i technologia na to pozwalają, a ja staram się też zmieniać nieco nomenklaturę i nie używać słowa „na zakwasie” (ang. sourdough). W innych językach ten kwaśny smak tak nie wy brzmiewa – po francusku mówimy leuven, po włosku lievito madre. Myślę, że trzeba to zmienić globalnie. I to dobry moment, w ś wiecie piekarskim jest duże poruszenie. Mamy najlepszy chleb w dziejach, a wiedza i technologia są dosłownie na wyciągnięcie ręki.
Potrafisz wskazać, gdzie zjadłeś naj lepszy chleb?
Zadajesz bardzo trudne pytania (śmiech). Przede wszystkim nie jadłem chleba we wszystkich krajach świata, byłem tyl ko w 52. Jeśli miałbym wybrać top 3, to z pewnością znalazłaby się tam chleb z Altamury. To małe miasteczko na południu
Na pewno nie chodzi o jeden składnik. Li czy się nie tylko rodzaj mąki czy zakwasu, ale też sposób pieczenia, kształt i wielkość bochenka. Niemniej uważam, że chleb na zakwasie sam w sobie jest tak genialnym produktem, że czynię starania, by wpi sać go jako dziedzictwo ludzkości na listę UNESCO.
Czym oprócz tego zajmuje się na co dzień Bibliotekarz Zakwasów? Karmię zakwasy (śmiech). W bibliotece jest 147 zakwasów, znam każdy z nich. Nie mam ulubionego, bo to tak jakby wskazać jedno ukochane dziecko. Oprócz tego ciągle prowadzę badania i testy w labora torium, następnie przekładam to na arty kuły. Niedawno na przykład testowałem 16 różnych zakwasów na tym samym bochenku. Jeżdżę po świecie z wykładami, przyjmuję gości w naszym centrum. Uwiel biam moje wyprawy, w niedalekiej przy szłości wybieram się do mnichów z góry Atos, gdzie jako jeden z niewielu ludzi na Ziemi zrobię reportaż skoncentrowany na ich wypieku chleba. To bardzo ekscytujące, jak wszystko, co dotyczy chleba. Po prostu kocham chleb i chciałbym tą pasją zarażać wszystkich dookoła.
We mnie z pewnością nasza rozmowa rozbudziła jeszcze większy zachwyt nad chlebem i zakwasem. Dziękuję za poświęcony czas.
UNI KĄSKI - Bo kibicowanie to ciężka praca!

UNI KĄSKI – koncept 7 przekąsek, idealnych do wsparcia sportowych emocji! Smaczne i proste w wykonaniu! Najlepszy wybór podczas meczu. Łapcie UNI-KĄSKI i szykujcie się na niezapomniane MUNDIALOWE wrażenia!!!


O szczegóły pytaj Doradców Piekarskich UNIFERM

Katarzyna Szarek: Na zdjęciu z kon kursu Master Baker na najlepszego piekarza, organizowanego w ramach targów Polagra 2022, jest uśmiech nięty i szczęśliwy facet w stylowym kaszkiecie. Pawle, czujesz, że zawód piekarza przeżywa renesans i dzięki modzie na piekarnie rzemieślnicze za czyna być profesją prestiżową?

Paweł Tkaczuk: Szczerze mówiąc, uwa żam całkiem odwrotnie. Zdecydowanie jest moda na pieczenie pieczywa czy otwiera nie piekarni rzemieślniczych – i to bardzo cieszy. Bo dzięki temu zwiększa się świa domość społeczeństwa na temat pieczywa i tego, co jemy. Natomiast co do samego zawodu, uważam, że jest w olbrzymim kry

zysie. Ci, którzy idą za „modą”, niestety w momencie gdy dochodzi do pieczenia kilkuset bochenków dziennie, stwierdzają, że to jednak nie dla nich, że po prostu wolą piec w domu, nie wspominając o godzinach pracy, które nie są dla każdego. Z drugiej strony nie szkoli się piekarzy, więc nie ma ich na rynku pracy. Ci, którzy są i mają umiejętności, traktowani są „prestiżowo”, ponieważ każdy chce ich zatrzymać u sie bie za wszelką cenę. Jednak jest ich bar dzo niewielu.
Niesamowitym problemem piekarzy „sta rego rzemiosła” jest to, że często przy zwyczajeni są do maszynowego obrabia nia ciasta czy do dużo niższych hydratacji i mimo 10-20 lat doświadczenia nie radzą
Rozmawiała: Katarzyna SzarekBaker Paweł Tkaczuk nie tylko zachwycił jury, ale też wykazał się postawą fair play, udzielając pomocnych rad oraz surowców uczestnikom kategorii „Amatrorzy”

ności była nietypowa, np. dwoje in żynierów geodetów porzuciło zawód, założyło piekarnię rzemieślniczą w Krakowie i się w tym spełnia. Jaka była Twoja droga?
U mnie było chyba trochę prościej i mniej radykalnie. Od lat zajmowałem się kar mieniem ludzi, jako szef kuchni chciałem być „kompletny”, pieczenie chleba to była ostatnia rzecz, której jeszcze nie umiałem.
Gdy zacząłem się uczyć i nastawiłem swój kwas, to cały proces fermentacji, to, jak zmieniało się ciasto czy sam wypiek, tak bardzo mnie wciągnęło, że nie było od wrotu. Najpierw piekłem „placki” dla sie bie, gdy zaczęły wychodzić, piekłem dla sąsiadów, gdy miałem wolne, wstawałem o 5 rano i w domowym piekarniku do godzi ny 22 wypiekałem chleby, a później rozwo ziłem je po okolicy. Po niespełna roku pod jęliśmy z żoną decyzję o otwarciu piekarni.

Czy w tej drodze zawodowej były jakieś rozczarowania? Chęć rzuce nia tego?
Rozczarowania może nie, ale zwątpienia, brak sił niestety bardzo często. Także chęć rzucenia zawodu. Przez pierwsze prawie 1,5 roku piekłem sam od 21 do 14, dzień w dzień, 7 dni w tygodniu. Zarówno fizycz nie, jak i psychicznie był to najcięższy okres w naszym życiu – nie było mnie w domu, żona została z naszą małą córeczką, która urodziła się równo 2 miesiące po otwarciu piekarni. Nie było to łatwe dla nikogo. Tak jak wcześniej wspomniałem, godziny noc
sobie z w ysokim nawodnieniem – 80% plus, więc trzeba rozróżnić piekarza i piekarza rzemieślniczego. Tych drugich jest może ok. 20%. Wyjaśnię jeszcze, że hydratacja to ilość wody w cieście. Im więcej, tym trud niej pracuje się z ciastem, ale dzięki temu chleb jest wilgotniejszy i dłużej zachowuje świeżość. Brakuje też społecznego doce nienia pracy piekarza, większość piekarni rzemieślniczych edukuje swoich klientów o tym, jak ona wygląda, jak jest ciężka, jednak utarło się, że praca ta polega na wrzucaniu worków z mąką do dzieży, prze rzuceniu do maszyny i wrzucaniu do pieca. Jak wiemy, wygląda to inaczej, ciężej, wy maga wiedzy, skupienia i ciągłego myślenia.
Rozmawiałam z właścicielami piekar ni, których droga do własnej działal

ne, przerzucanie setek kilogramów ciasta – niestety to praca nie dla każdego.
Patrząc na nazwy piekarni, są one nieraz angielskie, nieraz nadal pol skie. Jest piekarnia Gryzmi na Ślą sku, Pochlebstwo w Krakowie. W ich nazwach pojawia się gra słów, którą można się bawić. U Was jest prosto i jasno: „pajda”. Z czym więc kojarzy się Wam pajda chleba?
Dla nas pajda to coś miłego, domowego, ciepłego. Tak też chcieliśmy, żeby kojarzyła się naszym klientom i żeby tak się u nas czuli. Wydaje mi się, że to się udało. Ale każdy ma oczywiście swoją wizję na to.
Wasza wizja wydaje się bardzo do pracowana i... współczesna. Krótkie
filmiki na Instagramie, z adekwatnym podkładem muzyczną pokazują wy smakowaną wizję piekarni. Kto po mógł Ci w urządzaniu Waszych pie karni?
Nasz pierwszy lokal urządzaliśmy sami, sami malowaliśmy ściany, składaliśmy meble, olejowaliśmy blaty. Jest bardzo „surowy” i tak naprawdę niedopracowa ny. Ale zainwestowaliśmy w niego ostanie pieniądze, jakie mieliśmy, i nie starczyło na projektanta czy drogie meble. Za to pro dukt i zapach świeżo wypiekanego chleba nadrabia braki dekoracyjne. Kolejny lokal był częściowo urządzony, a resztą zajęła się Maria z siostrą Basią.
Wyszło bardzo ładnie. Nie zajmujesz się tylko wypiekiem chleba. Widzia
łam, że oferujesz bardzo urozmaicony asortyment: brownie, cudowne tarty ze śliwkami, cruffiny, wypieki z pol skiej kuchni – chałki i pączki. Staram się być kompletny i rozwijać w każ dej dziedzinie. Mój mentor na kuchni po wiedział mądre zdanie, które przyświeca mi przez całą karierę – zarówno jak pracowa łem na kuchni, jak i teraz na swoim: „Jeżeli chcesz być szefem, musisz być najlepszy w pomieszczeniu”. Dlatego wciąż dążę do perfekcji, nawet jeśli nie da się jej osiągnąć. To droga dla samej drogi. Gonić króliczka, a nie go złapać. Wszystkie nasze wypieki, zarówno wytrawne, jak i słodkie, są dokład nie tym, co sam chciałbym jeść. Czasami śmiejemy się, że jak mam ochotę np. na chleb z wędzoną papryką i cheddarem, to całe osiedle je to, co ja chciałem zjeść.


Takie motto przyświeca nam od samego początku, żeby piec jak dla siebie i dzielić się tymi smakami z innymi. Ciasto półfrancuskie jest fenomenalne i uwielbiam z niego tworzyć. Bawiąc się grubością, liczbą warstw, kształtami, można tworzyć setki różnych rzeczy. Moja pierwsza praca w gastronomii była na sekcji cukier niczej. Jednak już po konkursie związaliśmy się z niezwykle uzdolnionym szefem cukierni Arturem Jajecznikiem, który niedługo poka że w naszych lokalach nowe oblicze cukier nictwa premium. Praca i testy są w toku.
Bardzo często piekarnie rzemieślni cze pieką na własnym zakwasie. Wasz – zgodnie z zabawną modą – ma na imię Azor (śmiech). Co takiego jest w drożdżach przemysłowych, że pie karz rzemieślniczy ich unika i zdecy dowanie preferuje zakwas? Drożdże przemysłowe nie są złe. Kwas to też drożdże, tylko dzikie. To kwestia zdrowia i smaku, chcemy, żeby nasz chleb był lek kostrawny, żeby nasi klienci czuli się po nim dobrze, dzięki temu jest bardziej sycący niż ten na drożdżach. Tego też ludzie oczekują. Natomiast słodkie wypieki, chałki, drożdżów ki itp. robimy na drożdżach. Inną kwestią, przynajmniej dla mnie, i wydaje mi się dla wielu rzemieślniczych piekarzy, jest po prostu ambicja i wyzwanie. Żeby zrobić nieudany chleb na drożdżach, to trzeba się postarać, natomiast zakwas nie wybacza błędów.
Wydaje mi się, że pieczenie chleba to dla Ciebie przygoda. Co jest w niej najbardziej fascynującego?
Moja żona stwierdziła kiedyś, że u mnie to nie jest już pasja, a obsesja. Najbardziej fascynujące jest chyba to, że z 3 składni ków: mąki, wody i soli (plus oczywiście czas i temperatura) tworzymy coś niesamowi tego, lekkiego, sycącego, pełnego sma ku, a przy tym pierwotnego i swojskiego. Z zewnątrz wydaje się to proste, to „tylko” chleb, natomiast dla nas, piekarzy, jest to niezwykle skomplikowany proces, który daje ogromną satysfakcję, gdy panujemy w pełni nad nim i uzyskujemy efekt, który chcieliśmy osiągnąć.
Kreple, dawne pączki przygotowy wano ze słoniną, na wytrawnie. Nie mogę nie wspomnieć o takich produk tach. Ty wypiekałeś je z... kaszanką. Interesujesz się starszymi przepisa
mi? Lubisz zaskakiwać konsumen tów? Jak oni przyjmują nowości? Na mnie kiedyś wrażenie zrobił chleb z kawałkami czekolady. Staram się nawiązywać do naszej tradycji, szczególnie tej zapomnianej. Jeżeli my nie będziemy o niej pamiętać, to kto? Staram się też używać tylko polskich produktów, w cukierni jest to niestety trudniejsze, ale gdy gotowałem w mojej ostatniej pracy, używaliśmy 100% polskich produktów, w większości tych z małych manufaktur i od rzemieślników. To bardzo ważne, aby wspierać takie osoby. Często właśnie lokalne produkty zaskakują: „polski kawior” czy np. nasza wspaniała suska sechlońska (odmiana handlowa owoców śliwy domowej), której większość ludzi nie zna, a posiada certyfi kat produktu regionalnego. Używamy jej do naszego wiejskiego chleba, do którego dodajemy jeszcze prażone orzechy laskowe. Wspomniany przez Ciebie chleb czekola dowy robimy zazwyczaj w okresie świąt, jego bazą jest ciasto na chleb wiejski, do którego dodajemy gorzką czekoladę, orze chy laskowe i żurawinę moczoną w nalewce wiśniowej. To tak naprawdę wytrawny wy piek, świetnie komponujący się z twardymi, dojrzałymi serami. Zdecydowanie pozycja, która zaskakuje, ale także cieszy się dużą popularnością. Nasi klienci już nauczyli się, że lubimy zaskakiwać, więc wypatru ją i dopytują o nowości. Rynek piekarni czy cukierni jest tak nasycony, że trzeba się wyróżniać nie tylko jakością, ale także ciekawymi połączeniami smakowymi.
Nie tylko pieczesz, ale także uczysz, prowadzisz szkolenia. Dawką podsta wowej wiedzy na temat wypieków, zwłaszcza chleba, dzielisz się w po stach na Instagramie. To jest dla nas – kupujących. A jeśli chodzi o szkole nia do zawodu piekarza, czy są chętni, by uczyć się tego fachu?
Jest sporo chętnych, jednak ze względu na intensywność naszej pracy tylko w pew nych porach roku przyjmujemy kursantów. Wielu z nich to pasjonaci, którzy chcą otwo rzyć swoją piekarnię, lub pracownicy więk szych firm wysyłani na szkolenia, aby po szerzyć wiedzę. Niestety w tym roku już nie mamy wolnych terminów, żeby przyjąć dodatkowe osoby. Jednak jesteśmy zawsze otwarci na praktykantów. System edukacji piekarzy niestety jest na bardzo słabym poziomie, więc chociaż
w ten sposób chcemy pomóc młodzieży, aby się rozwijała, wskazać im odpowiedni kierunek. Ostatnio przyszedł do nas chło pak po szkole, ze zdanym egzaminem cze ladniczym i nie wiedział, co to znaczy pie karnia rzemieślnicza. To przerażające.
Masz jakiś ulubiony rodzaj chleba i słodkiego wypieku? Mnie bardzo przypadł do gustu chleb z chedda rem, bardzo lubię też serniki. Najczęściej wybieram nasz klasyczny wiej ski, ta jego prostota jest cudowna. Ale pró buję prawie każdego wypieku codziennie, czasami co drugi dzień. Ze słodkich zde cydowanie croissant z kremem pistacjo wym, białą czekoladą i liofilizowaną maliną. I oponki z lukrem porzeczkowym.
Z czego wynika dobra jakość chleba? Z krótkiego, uczciwego składu. Z dobrej jakości mąki czy ziarna, odpowiedniego ukwaszenia ciasta, powolnej fermentacji. To czuć w smaku, zapachu, ale też w sa mopoczuciu po zjedzeniu takiego chleba. Widać to także po trwałości. Dobrej jako ści chleb można jeść przez 4-5 dni i nic się z nim nie dzieje.
Podchodzisz z sercem i dużą pasją do swojego zawodu. Musisz także odpo cząć. Znajdujesz na to czas? Podobno jak się ma pasję, to nie przepra cowuje się ani jednego dnia. Oczywiście w praktyce nie jest to aż tak proste. Mimo wszystko kocham moją pracę, raz są lepsze momenty, raz gorsze, jak to w życiu. Na szczęście niedługo są święta i wtedy będzie chwila na odpoczynek. Niestety bycie wła ścicielem i głównym piekarzem w piekarni rzemieślniczej to praca 7 w dni w t ygodniu, warto też o tym mówić głośno. To setki ki logramów dźwiganych każdego dnia, 7 dni w tygodniu, w godzinach nocnych. Jest to bardzo ciężka praca, która wymaga wie lu wyrzeczeń. Śpimy w dzień na raty po 3-4 h. Niestety nie znajdujemy czasu na odpoczynek, nie tylko ja, ale wszyscy pie karze. Doceniajcie więc swoich lokalnych rzemieślników, nie tylko tych, którzy pie ką chleb, ale wszystkich, bo każdy z nas wkłada w to całe swoje serce.
I dlatego hasło „praca z sercem” prze wija się w hasłach promujących Wa sze piekarnie na Instagramie! Bardzo dziękuję za rozmowę!















Można powiedzieć, że upiekło mu się – i to doskonale. Studio cukiernicze o tej nazwie – Upiekło Mu Się – Łukasz Błaszczyk założył trochę ponad 3 miesiące temu. Taka potrzeba kiełkowała w nim od kilku lat. Dziś opowiada o wysokiej jakości produktach, zarażaniu młodzieży miłością do zawodu i lokalnym poznańskim produkcie – rogalach, które sam piecze.

Ewa Siuda-Szymanowska: Prowa dzisz pracownię sam?

Łukasz Błaszczyk: Studio prowadzę sam, mam też uczennice. Ale nie możemy za pomnieć o dziewcxzynach ze sprzedaży, kt,ore dzielnie stają naprzeciw klienta. mam jedną uczennicę. Założyłem studio nieco ponad 3 miesiące temu. Taka myśl chodziła mi po głowie od dłuższego czasu. Przez ostatnie 12 lat pracowałem w kon cernach powiązanych z branżą cukierni czą, ale korporacyjne życie przestało mnie bawić. Zresztą te firmy mają już zupełnie inne nastawienie niż wtedy, kiedy w nich zaczynałem. W związku z tym stwierdzi łem: jak nie teraz, to kiedy?
Skąd u Ciebie wzięło się cukiernictwo?
To długa historia. Wybrałem je trochę z przypadku, w skrócie: mój brat był cu kiernikiem i pracował w zawodzie. Ja przez kilka lat mieszkałem na Podlasiu i była we mnie potrzeba powrotu do Poznania, Wiel
kopolski, rodzinnych stron. Najprostszą dro gą było cukiernictwo, bo mogłem po pro stu wyjechać i uczyć się pod okiem brata w zakładzie, gdzie pracował. Zaważyła więc miłość do miejsca, do miasta, nie zawodu. Z czasm bardzo się w to wciągnąłem, jesz cze jako uczeń jeździłem na rozmaite kon kursy, zdobywałem nagrody. Te małe sukcesy skłaniły mnie do pogłębiania wiedzy
i nawet kiedy zacząłem studia (bardziej dla siebie), to nadal pracowałem w zawodzie.
Jaka była wizja studia Upiekło Mu Się?
Zależało mi na rzemieślniczych warto ściach. Na tym, żeby było to studio cukier nicze „domowe”, bazujące na naturalnych, wysokiej jakości składnikach. Nie używam


mieszanek, śmietany UHT, margaryn – pra cuję tylko na maśle. Mam bardzo dobre pistacje i pasty z Deseo. Kupuję lokalnie świeżą śmietanę z wrzesińskiej mleczarni, która ma bardzo dobre produkty, wielo krotnie nagradzane na targach. Używam jaj z wolnego wybiegu. Swoją cukiernię śmiało mogę nazywać manufakturą i z takimi wartościami się utożsamiam. To po wrót do tradycji, do tego, jak to wszystko robiło się kiedyś, z uwzględnieniem nowoczesnych technik.

Otwierając studio, chciałem zaoferować mieszkańcom mojego miasta – Wrześni pod Poznaniem – bezkonkurencyjny pro dukt. Te wszystkie wartości staram się jasno komunikować klientom, żeby wiedzieli na przykład, z czego wynika wyższa niż u innych cena.
Staram się mocno działać w social mediach, codziennie wrzucać jakiś post czy relację, nawet jeśli nie bardzo mam na to czas.
I wiem od klientów, że to bardzo dobrze działa, widać, że coś się u mnie dzieje. Jeśli nie będziemy tego robić, algorytmy Facebooka czy Instagrama będą bezlitosne. Wiedza z zakresu marketingu i działania mediów społecznościowych jest również bardzo ważna, zwłaszcza gdy prowadzi się działalność samemu. Social media są też kopalnią inspiracji. Jestem cukiernikiem od prawie 20 lat, kiedyś tego nie było. Sposób zdobywania wiedzy był zupełnie inny, bazowaliśmy na tym, czego nauczyliśmy się na praktykach czy szkoleniach. Teraz młodzi ludzie mają niemal nieograniczony
dostęp do wiedzy cukierniczej z całego świata. Można naprawdę wiele zdziałać, potrzebne są tylko zaangażowanie, odrobina determinacji i chęć poświęcenia czasu. Zatrzymanie się na tym sa mym poziomie, na którym było się np. 15 lat temu, jest porażką. Produkuję i wypiekam na miejscu. Klient dostaje zawsze świeże produkty, a przez szklane drzwi widzi, co dzieje się na produkcji, na zapleczu. Klienci czują nie tylko zapach świeżej kawy w kawiarni, ale i ciast czy innych wypieków – a to bardzo dużo daje. Mam takie możliwości lokalowe, że da się to zrobić w ten sposób, taka też była moja wizja od początku. Nie chciałem osobnej cukierni i kawiarni, do której będę dowoził wypieki. Klienci widzą, że ja to robię, ja za tym stoję i że kupują produkty niedawno wyjęte z pie ca. Już teraz w przypadku rogali niejednokrotnie zdarza mi się, że kiedy komunikuję, że np. świeże będą dostępne w niedzielę od 12, klienci pytają o nie pół godziny wcześniej. Zatem wyjmuję je z pieca, smaruję pomadą na gorąco i ciepłe zanoszę do sprzedaży.
No właśnie, pieczesz rogale z białym makiem i organizu jesz warsztaty, na których uczysz, jak je przygotować. Zaznaczam, że rogale, które robię, nie są rogalami marcińskimi. Nie mają certyfikatu i nie będą go mieć, bo po pierwsze nie jest
mi on do niczego potrzebny, a po drugie certyfikowane rogale mają w składzie margarynę, a ja jej nie używam. Masło stosuję i do ciasta, i do nadzienia. Moje rogale cieszą się coraz większym powodzeniem, mimo że robię je od niedawna. Postanowiłem trochę rozpropagować je poprzez warsztaty. Mają one też drugi cel. Zawód cukiernika jest trochę na wymarciu i uważam, że jeśli my, rzemieślnicy, nic z tym nie zrobimy, to problem będzie się pogłę biał. Myślę, że jest to ciekawy i kreatywny zawód mający dużo do zaoferowania, warto zachęcać młodzież, by przychodziła na naukę. Dzięki tym warsztatom chciałbym wzbudzić w młodych ludziach trochę zainteresowania, które może kiedyś przerodzi się w pasję, sprawi, że pójdą w t ym kierunku. Mój syn ze swoją klasą również był na warsztatach. Zaskoczyło mnie, że warsztaty cieszą się tak dużym zainteresowaniem, że w tym roku nie mam już wolnego terminu. Początkowo przeznaczałem na nie wtorki i środy, dni trochę martwe pod względem sprzeda ży. Okazało się, że muszę wygospodarować też poniedziałki, kiedy mam zamknięty lo kal, i dodatkowo jeszcze czwartki dla kilku grup. Grafik jest wypchany maksymalnie. Kiedy skończą się warsztaty rogalowe, gdzieś od końca listopada czy początku grudnia zaczną się pierniki. Na warsztatach mam różne grupy wiekowe, poczynając od przedszkolaków (5 i 6-latków), kończąc na szóstoklasistach – gru pie najstarszej, która jest już blisko wyboru drogi życiowej. Fajnie byłoby, gdyby chociaż część z nich zobaczyła przyjemność, jaką daje praca w zawodzie, i odkryła, co może im zaoferować. Wiadomo, że trudno to po kazać przez zaledwie kilka godzin. Chciałbym też, żeby uczestnicy warsztatów zobaczyli, jak wyglądają produkty w witrynie. Że cukiernictwo to nie tylko na przykład bułki mleczne, ale różnego rodzaju tarty, makaroniki, praliny czy monoporcje; że współczesne cukiernictwo ma też wymiar artystyczny. Wierzę, że te warsztaty dadzą efekt i za jakiś czas będę mógł powiedzieć, że dołożyłem choćby cegiełkę do tego, żeby młodzi ludzie lokalnie poznali cukiernictwo od zaplecza. I będę się bardzo cieszył, jeśli ktoś z nich będzie chciał kiedyś przyjść na praktykę.

Da się zaobserwować, że wśród młodych piekarzy i cukier ników otwierających lokale są głównie pasjonaci, którzy niekoniecznie kształcili się w tym kierunku. Zdobywali wiedzę własnymi siłami – z internetu czy poprzez warsz taty. Jest to zatem bardzo fajna forma działalności, a przy tym dzieciaki widzą, że można też przygotować i zjeść coś innego niż sklepowego batona.
To prawda. Chciałem też w lokalnej społeczności i wśród moich klientów zasłynąć tym, że używam mało cukru. Przy każdym pro dukcie na cenówce mam informację np., że do jego przygotowania użyto o 60% mniej cukru – po to, żeby na przykład ci, którzy chcą zjeść coś bardziej wytrawnego, wiedzieli, że to produkt dla nich. W tartach owocowych, które są naturalnie słodkie, używam mini
mum cukru. To nie są produkty bezcukrowe czy o niskim indeksie glikemicznym, choć mam i takie – do tych cukru praktycznie nie używam. Niestety nie mogę tego zrobić w bezie, bo to technologicznie niemożliwe. Ta redukcja cukru w produktach cieszy się zainteresowaniem. Klienci mówią, że mimo że porcje niektórych z nich są niemałe, to oni nie czują się po nich ciężko, nie są zasłodzeni. Pamiętam niedawny gwałtowny wzrost cen cukru, wówczas ode zwała się do mnie lokalna dziennikarka, prosząc o wypowiedź w tej sprawie. Odpowiedziałem, że cukier nie jest głównym produktem, na którym bazuję. Używam znacznie więcej mąki, mleka, świeżej śmietany i masła.
Wróćmy na chwilę do rogali marcińskich. Jakie są te robione przez Łuka sza Błaszczyka, co mają w składzie? Rogale marcińskie są w Poznaniu, Wielko polsce tradycyjnym i lokalnym produktem związanym z regionem, a przy tym mocno sezonowym – październik i początek listo pada stoją pod znakiem rogala. Prawdo podobnie jako pierwszy w mojej okolicy ruszyłem z rogalami i widzę, że ludzie szukają tego produktu. Moje rogale są bardzo podobne do marcińskich, ale jednak masło jest w nich mocno wyczuwalne, wzboga cam nim także masę makową. W składzie są: biały mak, masło, jaja, bakalie, orzechy arachidowe. Jest też odrobina aromatu migdałowego, dodaje go do masy makowej, ale na tyle subtelnie, żeby nie zabijał i nie przytłaczał smaku nadzienia, co dość często zdarza się w przypadku rogali marcińskich z różnych cukierni. Oprócz tego wszystkiego dodaję okruszki, które według mnie są niezbędne w nadzieniu, utrzymują wilgot ność; w formie okruchów wykorzystuję np. ciasteczka marcepanowe, bo są idealne do masy makowej, nawet kiedy trochę podeschną. Podtrzymują konsystencję, nadają smak. To jest bardzo ważne w cukiernictwie, gastronomii. Myślę, że na rynku przetrwają głównie ci, którzy potrafią właściwie gospoda rować odpadami. Był taki czas, że dzwoniłem do znajomych cu kierników, czy nie mają okruchów, bo ja nie miałem ich prawie w ogóle. Nawet jeśli powstają jakieś przy skrawaniu biszkoptów, to są dla mnie świetnym dodatkiem do masy i w ten sposób je wykorzystuję. Biszkopt składa się głównie z jaj i cukru, więc do skonale wzbogaca masę makową.
Koniec roku niestety nie zapowiada się różowo. Wielu wła ścicieli zamyka biznesy, rachunki za energię dobijają nie tylko cukiernie czy piekarnie, ale całą gastronomię. To bar dzo przykre, że nawet firmy, które istniały po 20-30 lat, tracą możliwość działania. Myślę, że wszystko zmierza w tym kierunku, by na rynku pozosta ły małe rzemiosła czy rodzinne firmy, gdzie właściciele wykonują większość pracy, pracują fizycznie. Pewnie zostaną i utrzymają się również wielkie firmy, które już dostarczają produkty do marketów czy dyskontów. Najgorzej będą miały te średnie, zatrudniające


15-20 pracowników i więcej, gdzie właściciele już nie pracują od kilku czy kilkunastu lat z różnych powodów, a zejście z 5-6 lokali do jednego jest bardzo trudne. Te małe rzemiosła, które zostaną, będą broniły się jakością, a te wielkie ceną (bo będą oferować np. ciasta marnej jakości z marketu w cenie kilkanaście zł za kg). Niemniej jednak w przypadku tych drugich to market czy dyskont będzie zarabiał, nie producent. Jeśli markety przerzucą swoje wy magania odnośnie do cen na producentów, to wielu z nich przy obecnych podwyżkach stwierdzi, że ten biznes jest nieopłacalny.
Mieszanki, na które cukiernie czy piekarnie przeszły 20-25 lat temu, też pojawiły się w związku z szukaniem oszczędności, potrzebą produkowania szybciej, łatwiej, więcej. Jednak od kilku lat na rynku pojawia się coraz więcej manufaktur, które pokazują, że można iść w drugą stronę – stawiać na jakość. I że są klienci, którzy zwracają uwagę na to, co jedzą. Możemy kupować coś przeciętnego lub coś bardzo dobrego, ale wiedząc o tym, że za tę jakość trzeba więcej zapłacić. Najgorzej jest oszukiwać klienta, bo można to zrobić tylko raz. Jeśli np. przychodzi do mnie klient i ma zapłacić dwukrotnie więcej niż za produkt z cukierni, która używa np. gotowych mieszanek, masy jajowej czy margaryn, to mam tylko jedną szansę, żeby go przekonać i utrzymać. Klient musi dostać produkt jakościowy i adekwatny do ceny. Najlepszym wyznacznikiem tego, czy to, co robimy, robimy dobrze, jest to, że klienci wracają. To właśnie dzięki stałym klientom możemy funkcjonować. Telebimy, radio, reklamy to jedno. Najlepiej działa tzw. poczta pantoflowa i polecenia klientów, którzy mówią innym, że u nas znajdą bardzo dobrej jakości produkty. To są dla mnie najlepsze rekomendacje.
Dziękuję za rozmowę!
– masa www.laskotki.com
ciasteczkowa w nowej odsłonie
Niezwykle klimatyczna, pięknie zaprojektowana przestrzeń. Unosi się w niej zapach z dzieciństwa – aromat masy ciasteczkowej, który przywołuje przyjemne wspomnienia z beztroskich czasów. Wszystko to w dzielnicy Wrocławia słynącej z szacunku do rzemieślnictwa i bardzo oryginalnych kawiarni.
Z Aleksandrą i Maciejem
– właścicielami pierwszego w Polsce baru z masą ciasteczkową – Łaskotki Cookie Dough Bar – o zamiłowaniu i pasji rozmawiała Anna Olszewska.

Anna Olszewska: Masa cia steczkowa (cookie dough) kojarzy się z dzieciństwem, to wspomnienie podjada nia pachnącego masłem i wanilią surowego ciasta mamie lub babci. Skąd pomysł, aby nadać mu rzeczywisty wymiar i poniekąd je wskrzesić?








Maciej Kamiński: Cookie dough to produkt typowo amerykański. W USA robi furorę. To właśnie w Stanach Zjednoczonych jest najwięcej barów z masą ciasteczkową. Nasz pomysł nie zrodził się jednak w Stanach, a w Holandii. Kilka lat temu żyliśmy i pracowaliśmy w Rotterdamie. Zakochaliśmy się w jednym z tamtejszych barów z masą ciasteczkową. Nie kalkując zbytnio, ufając intuicji, postanowiliśmy, że po powrocie do miasta, z którym byliśmy związani, stworzymy podobne miej sce. I tak właśnie doszło do otwarcia Łaskotki Cookie Dough
Poszliśmy poniekąd na żywioł, byliśmy pierwszym barem z masą ciasteczkową w Polsce. Takich produk tów w naszych kawiarniach nie podawano. Koncept udało nam się przenieść do kraju 4 lata temu. Pozytywne opinie osób, które
 Rozmawiała: Anna Olszewska
Rozmawiała: Anna Olszewska
prób. Udało nam się stworzyć masę, która odpowiadała polskim podniebieniom. Względem wyrobu amerykańskiego obniżyliśmy poziom tłuszczu i cukru. Dla porównania mieliśmy też smaki znane właśnie z Rotterdamu, ale też Berlina i tamtejszego baru. Dzięki modyfikacjom powstał nasz idealny smak i konsystencja.
A.O.: Zatem jakie są składniki Waszego wyrobu, który tak łaskocze polskie podniebienia?
M.K.: Świeże prawdziwe masło (82% tłuszczu), cukier trzcinowy, ekstrakt waniliowy, który pozyskujemy na miejscu świeże napoje roślinne lub mleko pełne i mąka.
A.O.: A propos mąki, na co zwracacie uwagę w przypadku tego składnika? Z jakich młynów ją sprowadzacie?
A.K.: Mąka musi być najwyższej jakości, pszenna, dostarczana wyłącznie z zaufanych, rzemieślniczych młynów. Ważne jest dla nas to, ile czasu potrzebuje dany rodzaj mąki w piekarniku, aby uzyskać oczekiwany przez nas efekt. Zanim mąka trafi do cookie
wym i orzechami. Ponadto oferujemy smak czekoladowy, czyli masę ciasteczkową z dodatkiem naturalnego kakao, nutelli oraz chipsów z mlecznej, gorzkiej i białej czekolady. Oczywiście furorę robi smak słonego karmelu – jest to masa ciasteczkowa z dodatkiem karmelu i różowej soli himalajskiej. Niespodzianką jest też miks, tzw. „smak tygodnia”, który wybierają klienci.
A.O.: Czy smaki determinowane są sezonem?
A.K.: Podstawą zawsze jest baza masy, którą tworzymy na miejscu. Jest gotowa do degustacji zaraz po wyrobieniu. Następnie w zależności od smaku dodajemy np. pasty karmelowe i inne składniki. Jesienią i zimą rządzą wersje kremowe, lekko korzenne, z kolei latem dodatkiem do mas są lody.
A.O.: Co jeszcze znajdziemy w Waszej ofercie?
A.K.: U nas nic się nie marnuje (uśmiech). Masy podajemy też jako desery w słoiczkach. Ponadto z cookie dough, której mamy za dużo, tworzymy podpiekane ciasteczka w wielu wariantach. Stawiamy też na dobrą kawę, pyszne lody i ciasta tradycyjne typu serniki czy brownie, które chętnie piekę.



dough, zostaje u nas podpieczona. Wynika to z zaleceń, by nie jeść surowej mąki, przy okazji w ten sposób wydobywamy z niej bardzo przyjemne aromaty i intensywność.
A.O.: Jakie smaki masy ciasteczkowej tworzycie?

A.K.: Mamy w ofercie smak „oryginalny”, czyli masę ciasteczkową z dodatkiem legendarnych belgijskich herbatników z piekarni Lotus i kremu ciasteczkowego Lotus. Jest też smak dla tych, którzy lubią, jak coś chrupie w ustach – „snickers” – masa ciasteczkowa z dodatkiem kremu snickers, karmelu i słonych orzeszków. Ser wujemy również smak „masło orzechowe” – to z kolei wersja na bazie oleju kokosowego i napoju roślinnego z masłem orzecho-
A.O.: Bierzecie często udział w wystawach targowych, tak popularnych we Wrocławiu. Jak Wasi klienci reagują na takie „słodkie spotkania” i Wasze smaki?
M.K.: Bardzo pozytywnie. Dla nas to też czas inspiracji. Wegań skie smaki powstają zazwyczaj dzięki sugestiom klientów, których spotykamy na tego typu wydarzeniach. To świetne inicjatywy, które pozwalają nam wyjść do klienta i mają wpływ na rozwój Łaskotek. Na rozwoju bardzo się skupiamy i cieszymy każdym „słodkim” dniem spędzonym tutaj.
Dziękuję za rozmowę.











Stosowanie zamienników to coraz popularniejszy trend w cukiernictwie, w wielu jego dziedzinach. Od kilku lat powstają kawiarnie oferujące wyłącznie asortyment dla klientów będących na dietach z różnymi wykluczeniami. Na rynku dostępne są zamienniki umożliwiające przygotowanie bezcukrowych wypieków, nawet takich, które trudno zrobić.
Wizualnie nie odróżnimy ciast na bazie białego cukru od tych z jego zamiennikami. W produkcji użycie ich jest trudniejsze, wymaga wpra wy, bywa też poprzedzone wieloma próba mi i b łędami. – Do produkcji naszych wyro bów używamy głównie cukru brzozowego, czyli ksylitolu, erytrytolu, maltitolu oraz stewii – mówi Karol Babicz z Ciacha bez cukru. – S łodziki te są przyjazne diabety kom i osobom na dietach niskocukrowych, ponieważ nie podnoszą drastycznie stęże nia glukozy we krwi. Indeks glikemiczny, a zarazem kaloryczność są znacznie niższe niż w tradycyjnych deserach, dlatego są
chętnie wybierane przez tysiące Polaków – dodaje.
NajpopularNiejsze z amieNNiki cukru

Wymienione przez właściciela Ciacha bez cukru zamienniki to substancje najczę ściej stosowane do wypieków. Jan Anto niak, technolog żywności, uważa, że ksylitol jest uniwersalnym zamiennikiem, nadaje się do większości wypieków. Jednak jeśli używamy ksylitolu w przepisach, które nie zawierają dużo wilgoci, produkt końcowy może mieć ziarnistą konsystencję. Ksylitol
pochłania wilgoć znacznie bardziej niż cu kier - wyjaśnia technolog. Dlatego lepiej dodać więcej płynnych składników do prze pisu, aby uzyskać najlepszy produkt koń cowy. Bardziej wymagający jest erytrytol, np. nie rozpuszcza się tak dobrze jak cukier i lepiej używać go – jak radzi Jan Antoniak – w wersji sproszkowanej. Kolejny zamiennik to stewia. Ma smak trochę inny od cukru, lekko wpadający w gorzki. – Jeśli chcemy używać stewii do pieczenia, należy zwrócić uwagę na kilka rzeczy. Stosunek stewii do cukru różni się w zależności od przepisu. Przy stosowaniu stewii zaleca się zwiększenie ilości skład
ników płynnych w przepisie. Ważne, aby nie używać jej w wysokich temperatu rach, powyżej 200°C, ponieważ rozkłada się i może zmienić smak wypieków – pre cyzuje. Jest jeszcze trzeci popularny za miennik – maltitol, wytwarzany z maltozy, naturalnie występującej w ziarnach zbóż, przede wszystkim w kukurydzy. Nie zmienia smaku potraw w wysokich temperaturach. Ksylitol, erytrytol, maltitol to najczęściej używane zamienniki białego cukru.



Zamiennik cukru to jednak nie cukier z buraka, co wiąże się z dostosowaniem produkcji do tych substancji. Dorota Ko walska-Paszkot, właścicielka dietetycznej kawiarenki na krakowskim Stradomiu Dora The Cook, wie, jak trudno przygotować cia sta z wykorzystaniem zamienników. I choć w ofercie tej kafejki znajdziemy wiele ro dzajów popularnych ciast, np. brownie, malinowa chmurka, czarny las, serniki, tartaletki, tiramisu, wuzetki, drożdżówki, donuty, to nabranie wprawy w ich wypie kaniu zajęło jej trochę czasu. – Opracowa nie receptur do niektórych z nich wiązało się z dużą liczbą prób, ale nigdy się nie poddaję i uwielbiam podejmować wyzwa nia klientów, którzy nie mogąc spożywać cukru, tęsknią za smakami z dzieciństwa – opowiada Dorota. Pracuje przede wszystkim na erytrytolu, który uważa za najkorzystniejszy dla dia betyków, sporadycznie na stewii i inulinie. Erytrytol nie jest łatwy do przygotowania masy. Nie rozpuszcza się tak samo jak cu kier. Może także pozostawiać na języku
uczucie chłodu, choć jeśli ktoś długo z nim pracuje – jak przekonuje Dorota Paszkot jest w stanie wyeliminować ten posmak, wywołując tym zdziwienie klientów, którzy zaskoczeni pytają: jak pani to robi? Nam się to w domu nie udaje! A to po prostu kwestia wprawy. Właścicielka Dora The Cook wypieka również ciasto drożdżowe, które bez cukru jest niemożliwe do przygo towania. Ratunek znalazła w inulinie, czyli błonniku z cykorii. To ona zastępuje cukier i pozwala smakoszom na dietach wyklucza jących pewne składniki cieszyć się trady cyjnym ciastem drożdżowym. W Dora The Cook zjemy ciasta o bardzo umiarkowa nej słodkości, gdyż klienci są odzwyczajeni od słodkiego smaku. Właścicielka kawiarni używa mniejszej ilości zamienników cukru, wychodząc z założenia, że takie produkty jak śmietanka czy mascarpone mają na turalną słodycz.
Z trudnościami borykał się także Karol Babicz z Ciacha bez cukru, zanim bezcu krowe wypieki stały się stosunkowo łatwe
do przygotowania. Był to w pewnym sensie tor z przeszkodami i wyzwa nie dla cukierników. – Pew ne słodziki rozpuszczają niektóre kremy – opowiada. – Mieliśmy sytuacje, w k tórych ubita śmietanka po jakimś czasie rozluźniała się i rozlewała, mimo że nie powinna. Opanowaliśmy to metodą prób i błędów. Spędziliśmy godziny w pracow ni, ucząc się zachowań polioli w obróbce ciepłej, przy rozpuszczaniu, pudrowaniu i innych procesach.
Efekt prac jest zadowalający, co docenili także klienci. Przedsiębiorca nie chce zdra dzać swoich patentów na obchodzenie się z poliolami, bo to wynik pracy i pomysło wości jego zespołu. Na pewno nie ma zbyt dużych problemów z ksylitolem, jeśli chodzi o obróbkę, z wyjątkiem chłodnego posma ku, który odróżnia go od białego cukru. Poziom słodyczy ksylitolu jest porówny walny z poziomem słodkości tradycyjne go cukru, jest też używany w podobnych proporcjach.
– Cukier buraczany – jak tłumaczy Karol Babicz – wzmacnia aromat ciast, kremów, mas, a jego krystalizacja nadaje wypie kom zwartą konsystencję. Jest również naturalnym konserwantem. Ze słodzikami jest inaczej. Krystalizacja, np. erytryto lu czy maltitolu, nie daje zwartej kon systencji. Jego cukiernicy starają się przygotować wypieki tak, by nie odbiegały smakiem od tych na bazie białego cukru. Poza tym jako
substancji słodzącej używają w wyrobach owoców typu banany, daktyle, morele takie wypieki cieszą się dużym po wodzeniem wśród dzieci. Mają w so bie nie tylko naturalny cukier, ale również składniki mineralne i wi taminy. Na pytanie, jakie ciasta wypieka jego firma, odpowiada bez wahania, że wszystkie: kru che, serniki, torty, eklery, a na wet wydawać by się mogło niewy konalne w wersji z zamiennikami ciasto drożdżowe. Zamiennik w nim pozostaje tajemnicą firmy. – Ważne, że ciepłe (dodatkowo bez glutenu) sma kuje znakomicie – zapewnia Karol. c zekolady z fińskim ksylitolem
Cukiernictwo z wykorzystaniem zamien ników cukru nie ogranicza się rzecz jasna tylko do wypieków. Producenci czekolad i l odów również wychodzą naprzeciw konsumentom z wykluczeniem cukru w diecie. Na rynku od lat są czekola dy przemysłowe produkowane z myślą o diabetykach. Powoli także producenci czekolad rzemieślniczych (bean to bar) i p ółrzemieślniczych (czyli wykonywanych z gotowych kuwertur albo z miazgi kaka owej, w tym przypadku ktoś przeprowa dził już proces obróbki ziarna) wprowa dzają na rynek tabliczki bez cukru. Paweł Sobieraj, chocolatier z Wrocławia, produ kujący czekoladową galanterię na razie na kameralną skalę, bazujący właśnie na miazdze kakaowej, od początku pracuje wyłącznie z fińskim ksylitolem. Smakosze nie zawsze preferują smak cze kolady bez cukru. Nie do końca odpowiada im delikatny, chłodny posmak, jaki pojawia się po użyciu ksylitolu, choć nie musi on być – jak twierdzi właściciel marki Sobieraj Cho colate – wyczuwalny. Tylko niewielki procent osób czuje ksylitol w czekoladzie, zdecydo wana większość nie zauważa różnicy. Cze kolada mocno przykrywa również chłodne odczucie ksylitolu. Na smak czekolady wpły wa wiele czynników, w tym substancja sło dząca, ale jednak dominującą rolę odgrywa pochodzenie ziarna kakao i jego obróbka, dodaje. W swoich wyrobach wykorzystuje tylko ksylitol fiński, pozyskiwany z masy drzewnej drzew liściastych, głównie z brzo zy, stąd jego druga nazwa: cukier brzozo

wy. – Ksylitol chiński, który otrzymywany jest z kukurydzy, cieszy się gorszą opinią dlatego, że kukurydza bywa genetycznie modyfikowana, a jeden z procesów chemicz nych towarzyszących jego produkcji szkodzi środowisku – wyjaśnia Paweł.
Krystian Krzykawski z Krakowa, produku jący lody rzemieślnicze (lodziarnia Frosti ni), ma w ofercie smaki bez cukru. – Je żeli można tak to nazwać – dodaje – gdyż są one nadal przygotowywane na bazie mleka i śmietany, a te produkty zawierają laktozę, która jest cukrem. Jako zamien ników cukru białego używam polioli: ksy litolu i erytrytolu.
To, na co Krystian zwraca uwagę, to fakt, że cukier ma właściwości obniżające punkt zamarzania wody, tak jak sól czy alkohol. – To właśnie między innymi dzięki cukrowi możemy cieszyć się przyjemną konsysten cją lodów w ujemnej temperaturze – pod kreśla właściciel Frostini. – Każdy cukier ma inne właściwości wpływające na tem peraturę zamarzania wody czy odczucie słodkości. Używając polioli, trzeba bardzo uważać z ilością, którą zastępujemy cukier, ponieważ mają przeważnie o wiele więk szą moc przeciwzamrożeniową od białego cukru z buraków. Jak tłumaczy jeszcze precyzyjniej lodziarz, to, czy lody będą mieć odpowiednią kon systencję, zależy od ilości użytego cukru i wolnej wody w mieszance. Im więcej wody w lodach, a mniej suchej masy, tym bar
dziej zmrożone i twarde będą lody. Poliole, których używa (ksylitol i erytrytol), mają większą zdolność do obniżenia punktu zamarznięcia wody, np. ta sama ilość ksylitolu w pewnej ilości wody spo woduje, że mieszanina zamarznie w niższej temperaturze niż w tych samych proporcjach mieszkan ka (mieszkanka nie w rozumieniu sztucznej mieszanki! – przyp. red.) z użyciem cukru. – Lody śmietan kowe robione tradycyjnie z cukrem w temperaturze -12°C będą zwarte, będą też miały idealną konsystencję, te same lody z ksylitolem lub erytryto lem użytym w tych samych proporcjach co cukier i zamrożonych również w tem peraturze -12°C będą wyglądały na topnie jące. I trzeba wspomnianych polioli użyć mniej, a mieszaninę uzupełnić tłuszczem i błonnikiem.
Panuje powszechne przekonanie, że za mienniki są zdrowsze od cukru buracza nego, ale mają swoje wady i stawiają ogra niczenia. – Zamienniki cukru obok niskiej kaloryczności wykazują mniejszą szkodli wość dla zębów – zaznacza dr Justyna By linowska, redaktor naczelna portalu www. dietetycy.org.pl. – Są to także substancje przyjazne dla diabetyków w przeciwień stwie do cukru, dla osób z insulinoopor nością lub już rozwiniętą cukrzycą typu II. Pomagają kontrolować gospodarkę węglo wodanową bez konieczności rezygnacji z potraw o intensywnie słodkim smaku. Stosując słodziki, powinno się zachować umiar. Niektóre mogą wykazywać działanie przeczyszczające, wywoływać bóle brzu cha czy powodować metaliczny posmak w ustach.
Zamienniki cukru nie powinny być poda wane dzieciom do trzeciego roku życia. Nie tylko dlatego, że nie należy im dosładzać produktów, ale także dlatego, że zamien niki nie są obojętne dla układu trawien nego. Jak mówi technolog Jan Antoniak: – Używając słodzików, ograniczamy ilość kalorii, lecz wciąż brakuje długotermino wych badań na dzieciach, aby określić bez pieczeństwo spożywania słodzików przez nie. Niektóre analizy wykazały, że pewne zamienniki cukru mogą zmieniać skład waż nych bakterii w jelitach.



Wstajesz rano, bo inaczej budzik nie przestanie dzwonić. Kawa, papieros, trening czy spacer z psem? Każdy ma inny poranek. Bo każdy jest odpowiedzialny za to, jak wygląda jego dzień, praca, życie.


Tak zaczyna się zwykły dzień. Wchodzisz na kuchnię, zapalasz światło, palniki. Zamawiasz kawę i sprawdzasz lodówki. Jakieś faktury wiszą od tygodnia, wpadły 3 im prezy na weekend. Zwykły dzień. Ludzie się schodzą, każdy się wita. Przez lata ciężkiej pracy wypracowałeś sobie szacunek. Wiesz, co potrafisz. Jesteś odpowiedzialny za swoją kuchnię. Je steś SZEFEM. To brzmi dumnie. Ciężka praca. Obserwujesz każdy etap produkcji. Dopilnowujesz, by nawet najmniejszy element dania był doskonały, a firma rentowna. Łyk kawy, resztę dopi jesz wieczorem lub wylejesz. Zaczynamy. Pierwsze zamówienia spływają na kuchnię. Serwis! Niby zwyczajny dzień, niczym dzień świstaka, powtarzany bez końca, bez znaczenia, czy to kuchnia, cukiernia, czy piekarnia. Pewne schematy powtarzamy codziennie. Podobnie pewne za sady i często błędy.
Wielokrotnie widziałem, jak końcówki cebuli były wyrzucane, bo to przecież śmieć. Tak, wiem – bio. Ale to nadal odpad. Łodygi kopru czy pietruszki lądowały w koszu bez przykrywki, co nieko niecznie spodobałoby się pewnej instytucji. Jak wiele elementów naszej pracy jest błędem? A może nie? Może to brak wiedzy, brak zrozumienia dla otaczającego nas świata? Nie, to brak odpowiedzialności Kochani bracia kucharze, cukiernicy i piekarze. Może Was zasko czę, ale to na nas spoczywa odpowiedzialność za szacunek do produktów, którymi dysponujemy. Kucharz, który swoje ży cie poświęcił, by przy błyszczącym stole, w świecie jarzeniówek i ciągłych poparzeń tworzyć pyszne dania na talerzu, niesie na swych barkach potężną odpowiedzialność za świadomość gości na temat racjonalnego wykorzystania produktów. Wychodząc z biura, część z nas jest po pracy. Kucharz po wyjściu z pracy nadal jest w pracy. Mimo że jest środek nocy, a pieka rza razi słońce, to odpowiedzialność mamy tę samą. W pewnym
filmie o superbohaterze padły słowa: „z potężną siłą wiąże się potężna odpowiedzialność”. Przez pewien czas w odbiornikach z kolorowym ekranem kto mógł, ten śpiewał, tańczył na lodzie, skakał do wody i pisał książki ku charskie. Dlaczego? Bo było to modne. Ci ludzie przeminęli. A my? A my nadal jesteśmy na swoich stanowiskach, otoczeni ostrymi nożami, kolorowymi deskami, mąką i czekoladą. Walczymy. Dla tego uważam, że powinniśmy budować przede wszystkim świado mość konsumenta. Pokazywać, co można zrobić z pozostałych po obiedzie obierków po warzywach. Nauczać i bez przerwy powta rzać, że skorupy po krewetkach to nie odpad, a kolejny składnik sosów czy wywarów. Nieustanne dążenie do doskonałości musi opierać się na wiedzy, a że takową posiadamy, to dzielmy się nią na prawo i lewo. Dzisiaj jest to łatwiejsze niż kiedykolwiek. Bo każdy, kto posiada media społecznościowe, może dotrzeć do mi liona osób. Zatem róbmy to, by wyplenić błędne nawyki, pokazać zbilansowaną gospodarkę surowcami i zdradzać proste przepisy na pasteryzację. Nim się obejrzymy, będą już święta. W branży gastronomicznej, jak wiecie, święta często zaczynają się już pod koniec listopada. Gdy siadamy przy świątecznym stole, oka zuje się, że od miesiąca jemy barszcz, ryby w siedmiu odsłonach, a kciuki bolą nas od miliona wyprodukowanych uszek. Najpierw nie jedz, bo na święta, a potem jedz, jedz, bo wyrzucę. Każdy z nas to zna. Od lat ob serwuję stany magazynowe zalegające na polskich śmietnikach po świętach. I jestem zrozpaczony. Mimo kryzysu finansowego nadal gotujemy za dużo, bojąc się, że za braknie i co goście powiedzą? Ludzie! Na stole tradycyjnie ma być 12 potraw. Na wet jeśli zabraknie pierogów, jest jeszcze 11 cudownych dań, które mają przenieść nas do czasów dzieciństwa, byśmy poczuli magię tych świąt sprzed okresu, gdy za częliśmy myśleć o podatkach, rachunkach i kredytach. Okazuję się, że po każdym dłuższym weekendzie na śmietnikach po jawia się czerstwe lub spleśniałe pieczywo, w k tóre ktoś włożył serce. To my musimy uświadomić ludziom, że starą bułkę pszenną można zetrzeć lub namoczyć w mleku i wykorzystać jako dodatek do mielonego czy pasztetu. Musimy nauczyć ich, że z czerstwego pieczywa można przygotować knedla bawarskiego, który powali na kolana gości nawet kilka dni po świętach.
Jest mnóstwo sposobów, by dotrzeć do ludzi. Nie musimy ich szukać, sami nas znajdą. Jest mnóstwo sposobów na przetworzenie produktów. Koniec koń ców można to wszystko, co zostanie, zasypać serem, który na pewno jest, pozwolę sobie na stwierdzenie, że był jeszcze przed świętami. Nie polecam je

dynie przetwarzania królowej polskich imprez, czyli sałatki warzywnej.
Nasza odpowiedzialność zaczyna się, gdy otworzymy oczy Od samego świtu możemy edukować bliskich, ludzi w drodze do pracy czy młodych adeptów sztuki kulinarnej, dawać im przykład. Bo w dzisiejszych czasach cierpimy na potężny brak wzorców do naśladowania. Stańcie się superbohaterami, nauczycielami, tym człowiekiem, którym zawsze chcieliście być.
Nie bez przyczyny na początku wspomniałem o szacunku. Szacunek i odpowiedzialność to dla mnie kluczowe słowa, by móc uczyć innych, musisz się nimi kierować. Zmiany zawsze powinniśmy zaczynać od siebie. Wyliczone produkty i ilości jedzenia na posiłki dla rodziny pokazują najbliższym, że można rozważnie działać. Na co dzień to samo robisz w restauracji, więc czemu nie przenieść tej metody na innych? Jeszcze prościej, a również sensownie i efektywnie jest oddać nadmiar jedzenia, zamiast go wyrzucać. Kucharze, piekarze, cukiernicy… od dzisiaj świadomi swej mocy, odpowiedzialności i pełni szacunku dbajcie o wiedzę ludzi, którzy was otaczają. Niech nasza ciężka praca zmieni coś w mentalności Polaków. Tego wam i sobie życzę.


Gdy jesień puka do drzwi, warto sięgnąć po świeżą żurawinę, która po odpowiednim przygotowaniu nie ma sobie równych. W tym małym i niepozornym owocu, uznawanym za najzdrowszy na świecie, drzemie wielka moc. Choć popularność żurawiny rośnie, to jej ogromny potencjał wciąż czeka na odkrycie.

Na torfowiskach północy rosną długowieczne krzewy, które nie tracą zieleni przez cały rok. Zwisają z nich nie wielkie ciemnoczerwone owoce przypominające jagody. To żurawina. Swą nazwę zawdzięcza żurawiom kanadyj skim – jej rozwijające się pąki kwiatowe są podobne do głowy tego pięknego ptaka. Kolebka żurawiny to Ameryka Północna, tam właśnie odkryto pierwsze krzewy. Indianie zbierali dziki owoc na długo przed kolonizacją Nowego Świata. Z danych Instytutu Żura winy w Massachusetts wynika, że pierwsza komercyjna plantacja żurawiny powstała w 1816 roku na terenie USA. Współcześnie
kraj ten jest największym producentem tego owocu na świecie. Żurawina zyskała w USA ogromną popularność za sprawą Święta Dziękczynienia obchodzonego w ostatni czwartek listopada. Wte dy na stołach Amerykanów króluje indyk z sosem żurawinowym. Tradycja jedzenia żurawiny kultywowana jest także w Polsce. Sto sowano ją chętnie w kuchni staropolskiej. W naszym kraju w śro dowisku naturalnym rośnie żurawina błotna i drobnolistna o mniej szych owocach (8 mm), ale do uprawy na większą skalę wybiera się odmianę wielkoowocową (20 mm). W Polsce zbiera się rocznie ok. 1,5 tys. ton żurawiny. Wprawdzie nasz klimat sprzyja uprawie,















Żurawina to na całym świecie jeden
z ulubionych składników wypieków i deserów świątecznych. Jej kwaśny i nieco wytrawny smak stanowi świetne przełamanie kremów maślanych i śmietanowych. a także ganachy na bazie białej czekolady
jednak długo nie było w Polsce tradycji przemysłowej wytwarzania żurawiny. Sytuacja zmieniła się w 2015 roku. Wtedy na terenie Podkarpacia powstała największa i najnowocześniejsza w Euro pie plantacja Fieldstone. – Żurawina jest owocem zapomnianym w polskiej kuchni, natomiast w ostatnich latach obserwujemy jej powrót na salony. Ma to przede wszystkim związek z coraz więk szym zainteresowaniem konsumentów zdrową dietą, ale także większą dostępnością świeżej żurawiny w sklepach – tłumaczy Ewa Kowalska, przedstawiciel firmy Fieldstone. Warto pamiętać, że żurawina jest owocem sezonowym. Zbiory trwają od września do początku listopada. Wtedy do sklepów trafia świeży owoc. Żurawina przez wieki odgrywała ważną rolę w medycynie ludo wej. Rdzenni mieszkańcy Ameryki Północnej używali jej do walki z przeziębieniami, chorobami reumatycznymi, wspomagała także układ trawienny. Dzisiaj nadal traktuje się ją jako roślinę leczniczą, zaliczając do naturalnych antybiotyków. Dzięki swym właściwo ściom wykorzystywana jest w fitoterapii – dziedzinie z pogranicza medycyny i ziołolecznictwa. A to za sprawą drogocennego skła du chemicznego, który wykazuje bardzo silne właściwości anty bakteryjne. W badaniach udowodniono jej skuteczność w walce z bakterią E. coli wywołującą infekcje układu moczowego i po karmowego, a także z Helicobacter pyroli wywołującą wrzody i raka żołądka. Do tego zapobiega i leczy choroby jamy ustnej.
Lista przypadłości, w leczeniu których żurawina przychodzi z pomocą, jest znacznie dłuższa. To prawdziwa bomba złożona
z witamin, mikroele mentów i związków aktywnych, kombi nacja tych składni ków jest unikatowa i nieobecna w innych owocach. Z danych Polskiego Towarzy stwa Dietetyki wynika, że liczne związki anty oksydacyjne zawarte w żurawinie chronią przed chorobami układu sercowo-naczynio wego. Ponadto owoce te mogą wykazywać działanie przeciwno wotworowe, przeciwzapalne, przeciwgrzybicze i przeciwalergicz ne. Mimo ogromnej dobroczynności żurawiny nie wszyscy mogą się nią delektować. Ostrożność w jej spożyciu zaleca się osobom przyjmującym leki przeciwzakrzepowe oraz cierpiącym na niedo bory wapnia. Warto pamiętać, że owoce te zawierają szczawiany, które zwiększają ryzyko kamicy nerkowej. W dobie panującego trendu na odżywianie fit warto zaznaczyć, że żurawina jest produktem niskokalorycznym, ale tylko ta świeża. Według danych portalu Nutritiondata w 100 g owocu jest zaledwie 46 kcal. Jednak to owoc nie tylko dla tych liczących kalorie. Także cierpiący na cukrzycę mogą sięgać po niego lekką ręką – 100 g żurawiny zawiera śladową ilość cukru, bo zaledwie 4 g! Niestety inaczej wygląda sprawa w przypadku owoców kandyzowanych. Te już są bardzo słodkie (65 g cukru na 100 g) i bardzo kaloryczne (308 kcal na 100 g). Dlatego chorzy na cukrzycę lub cierpiący na otyłość powinni samodzielnie przetwarzać surowe owoce, kon trolując dodawaną ilość cukru. Niestety żurawinę trudno jeść na surowo bez dodatków. Jej owoce są bardzo kwaśne i cierpkie. Trzeba je przetworzyć.
Często pojawia się pytanie, jak wykorzystać świeży owoc. Nie ma jednej odpowiedzi. Najprościej zrobić smoothie, sok tłoczony na zimno lub żurawiny w syropie, te mogą być dodatkiem do wypieków cukierniczych. To wymarzony owoc do produkcji konfitur. Dobrze znosi wysokie temperatury, a gotowanie nie niszczy zawartych w nim związków bakteriobójczych. Owoce żurawiny są bardzo trwałe. Świetnie znoszą mrożenie. Hermetycznie zapakowane mogą być przechowywane nawet przez rok. W lodówce mogą spędzić nawet 2-3 miesiące. Nadają się także do suszenia. Jak sprawdzić świeżość owocu? Wystarczy upuścić kulkę żurawiny na blat kuchenny z wysokości 20 cm. Jeśli owoc odbije się wysoko, to znaczy, że jest świeży. Czas uporządkować wiedzę o dostępnych rodzajach żurawiny. W polskich sklepach dominuje żurawina kandyzowana, mylnie nazywana suszoną. Kandyzowane owoce podlegają procesowi smażenia w słodkim syropie. Oznacza to, że zostają nasączone cukrem w około 70%. Żurawina kandyzowana jest dobrym za miennikiem rodzynek czy składnikiem ciast, ale tylko wtedy, kie dy zależy nam na słodyczy. – Żurawina świeża i liofilizowana to zupełnie inny rodzaj produktu, o innym smaku. Zarówno świeży owoc, jak i liofilizat charakteryzują się kwaśnym, lekko cierpkim smakiem, doskonale przełamuje słodycz i nadaje zadziornego

Jackowski Sp. z o.o.
Jackowski Sp. z o.o.








Żurawina sprawdzi się w cukiernictwie w najrozmaitszych formach – suszona, kandyzowana lub liofilizowana. Świetnie komponuje się ze skórką pomarańczy
i cytryny. a także z orzechami pekan lub migdałami. Doda charakteru klasycznej szarlotce
charakteru wypiekom. Współpracujący z nami szefowie kuchni często podkreślają walory żurawiny jako naturalnego, rubinowego barwnika i jej walory dekoracyjne – dodaje Ewa Kowalska. Warto pamiętać, że żurawina liofilizowana zachowuje właściwości od żywcze świeżego owocu. Branża cukiernicza szybko doceniła jej walory, a zwłaszcza wa chlarz smakowy. W zależności od rodzaju zapewni słodki albo kwaśny i cierpki smak. Najczęściej jednak wybierany jest owoc słodzony, który stanowi doskonały dodatek do deserów i czeko lady. – W naszych wypiekach chętnie stosujemy żurawinę kan dyzowaną, ze świeżą jeszcze nigdy nie próbowaliśmy. Może czas to zmienić? – zastanawia się Izabela Greń, właścicielka cukierni Manufaktura Smaku z Brennej. Jak wykorzystać tę świeżą? Zdaniem Pani Izabeli wystarczy namo czyć żurawinę w soku żurawinowym (naturalnym), dodać cukier, pektynę i użyć jako wypełnienie do monoporcji. Zaś żurawinę kandyzowaną można wykorzystać z powodzeniem jako nadzie nie do ciastek owsianych, ciasta marchewkowego czy użyć jako bakalii do keksów.

Żurawinę ma w swojej ofercie także cukiernia Smaki Warszawy, działająca od kilkunastu lat na Żoliborzu. Tam eksperymenty ze świeżym owocem przerodziły się w rynkowy sukces. Lokal słynie z żurawinowych bez, a ich sława wykracza poza stolicę. – Doce niliśmy walory świeżej żurawiny dawno temu, dlatego nasza le gendarna beza z żurawiną i kremem waniliowym jest z nami od samego początku. Pojawia się w menu wraz z nadejściem jesieni i towarzyszy nam aż do wiosny. Beza ma swoich zagorzałych fanów, którzy trafiają do nas, by spróbować idealnego połączenia słody
czy z kwaśną i cierp ką nutą – podkreśla Konrad Wesołowski, mistrz cukiernictwa. Wraz z Bogusławem Buczkiem, również mi strzem cukiernictwa, w swojej cukierni kon sekwentnie stawiają na jakość, używając do wyrobów wyłącz nie prawdziwego ma sła, jajek i świeżych owoców. A wszystko tworzone jest od podstaw. W odróżnieniu od cukiernictwa branża piekarnicza przez długi czas podchodziła do żurawiny z rezerwą. Piekarnie posiadające w ofercie chleb z żurawiną należą do mniejszości. Wśród nich jest krakowska piekarnia Buczek. To prawdziwy długodystansowiec – działa na lokalnym rynku nieprzerwanie od 75 lat. Prowadzo na od trzech pokoleń przez jedną rodzinę produkuje chleb żytni z dodatkiem żurawiny, który cieszy się dużym zainteresowaniem i ma swoich stałych konsumentów. – Filozofią naszej piekarni jest przywiązanie do tradycyjnych receptur, świeżych produktów i lo kalnych smaków Krakowa. A żurawina jest tradycyjnym polskim owocem o dużym potencjale, choć dość zapomnianym. Dlatego z powodzeniem stosujemy ją już od dawna w produkcji naszego chleba. Wypiekany wyłącznie z mąki żytniej, jest dość kwaśny, a słodycz, którą daje żurawina, świetnie balansuje smak. Stąd jego sukces rynkowy – tłumaczy Małgorzata Bros, specjalistka do spraw jakości w firmie. Z południa Polski przenieśmy się na północ do Bartoszyc leżą cych w wojewódzkie warmińsko-mazurskim. Zaledwie od 2 lat działa tam Piekarnia Więzienna wykorzystująca budynek daw nego więzienia karno-śledczego. Wszystkie chleby, wyłącznie na naturalnym zakwasie i z żytniej mąki, wypiekane są pod okiem dyplomowanego piekarza, mistrza Artura Chlebka Zie mackiego. W ofercie piekarni znajdziemy chleb z żurawiną na razowym zakwasie, który cieszy się bardzo dużym zaintereso waniem klientów, generując 25% sprzedaży. Do wypieku sto suje się żurawinę kandyzowaną, która zapewnia mu delikatną słodycz, nie stanowiąc żadnego utrudnienia. Bochenki z Pie karni Więziennej można zamówić do paczkomatu. Jest to moż liwe dzięki długiej świeżości, jaką zachowują żytnie chleby na naturalnym zakwasie. O żurawinie jakiś czas temu zrobiło się naprawdę głośno. Jed nym z powodów była pandemia koronawirusa. Zgodnie z „Naro dowymi badaniami konsumpcji warzyw i owoców” realizowany mi przez KANTAR pandemia znacząco wpłynęła na zachowania konsumentów w sferze zainteresowania zdrową żywnością. Aż 58% badanych potwierdziło większe zainteresowanie zdrową żywnością. Ponadto już dwie trzecie Polaków wskazuje, że kluczem do zdrowia jest spożywanie świeżych warzyw i owo ców. A żurawina to prawdziwy superfood. Dlatego też wciąż zyskuje na znaczeniu i popularności, doskonale wpisując się w t en trend. Jej unikatowość i wartość są tak duże, że czasem określa się ją mianem czerwonego złota. Jednak jego gorączka dopiero przed nami.

Choć pierniki szczególnym zainteresowaniem cieszą się w grudniu, Anna Sosnowska, czyli Piernikowa Mama, równie mocno skupia się na nich w każdym innym miesiącu.



Piernikowa pasja zaczęła się, gdy Anna Sosnowska była jeszcze nastolatką. W wieku 17 lat sezono wo pomagała w cukierni. Praca ta spodobała jej się na tyle, że stała się pa sją. A to zaowocowało stworzeniem własnej marki, którą od ponad 2 lat prowadzi w ramach RHD. – Nie pamiętam swojego pierw szego ciasteczka, ale wiem, że te spod mojej ręki wyszły na walentynki – wspomina. To właśnie wtedy, w pierwszej pracy połknęła piernikowego i dekoratorskiego bakcyla. Po narodzinach synka zrezygnowała z pracy w cukierni, w której spędziła ponad deka dę, i jak przyznaje, to była jej najlepsza życiowa decyzja. – W końcu mogłam rozwijać się pełną parą i projektować pierniczki według własnej wizji. Moje prace zaczęły być w końcu doceniane, choć na począt ku bardzo trudno było się przebić w tym słodkim biznesie.
Tworząc własną markę, Piernikowa Mama zainwestowała także w dodatkową edukację. Po wielu odbytych szkoleniach i kursach (m.in. u Anny Komisarczyk) zyska ła wiedzę o lukrze królewskim i pierniku. Wtedy też zaczęła interesować się każdym surowcem, który składa się na lukier i piernik, co pozwoliło jej ostatecznie opracować własną recepturę na ciasto. – Zwróciłam uwagę na produkty, z których korzystam, i zaczęliśmy produkować chociażby mąkę z własnego ziarna na potrzeby najlepszej jakości produktu, jakim jest piernik. Przepis na lukier pochodzi z odbytych przeze mnie szkoleń. O lukrze i pierniku można napisać dobrą książkę. Bez tej podstawowej i zaawansowanej wiedzy praca sprawia o wie-
Jak podkreśla, pierniki nie powinny być ani twarde, ani miękkie, inaczej nie utrzymałyby dekoracji z lukru. Jej wypieki są chrupiące


le więcej kłopotów. W tej chwili czuję, że etap trudności mam za sobą – deklaruje. Jej pracownia jest niewielka, ale ma w planach trzykrotne powiększenie metrażu. Nowe miejsce jest w trakcie budowy, co znacznie podniesie komfort pracy. Najczę ściej używane w niej sprzęty to oczywi ście piekarnik, mikser i suszarki spożywcze. Dodatkowo korzysta także z aerografu i zawsze z barwników spożywczych. Nie wykorzystuje za to niczego, co stanowi niejadalne dekoracje, np. materiałowych kokardek.
Ile czasu spędza w pracowni? – Często sły szę to pytanie i niestety nigdy nie umiem na nie rzeczowo odpowiedzieć, ponieważ moja praca to pasja. A kiedy robi się to, co się kocha, czasu się nie liczy… – wyjaśnia z uśmiechem. Wszystkimi etapami pracy zajmuje się sama – od zrobienia ciasta po zapakowanie pierniczków dla klienta. Sama również zaopatruje się w potrzebne do pracy produkty.
Tak kompleksowe działanie, jak prowa dzenie własnej marki, nie stanowi dla niej wielkiego problemu. Gdy jest zmęczona wielością obowiązków… po prostu zabiera się za „pierniczenie”. – Regeneruję się w pracy! I tylko w pracy, w ten sposób się też wyciszam. Mam ten komfort, bo pracownię urządziłam w domu, więc kie dy naprawdę potrzebuję odpocząć, robię sobie krótką przerwę w pracy i zajmuję się synkiem.
Właśnie przez tę bliskość, połączenie ży cia prywatnego z tym domowym marka zyskała swoją nazwę: Piernikowa Mama – Sztuka Lukru. Choć pierniki standardowo kojarzone są z okresem Bożego Narodzenia, przyznaje, że pracy ma sporo przez cały rok. – Pra cy poza sezonem bożonarodzeniowym jest bardzo dużo, ponieważ wykonuję pierniczki na różne okazje, tj. Wielkanoc, chrzest, urodziny, Dzień Mamy, Dzień Babci i Dziadka (i wtedy dzieje się najwięcej!), komunie, imprezy firmowe itp. Okazji, by zamówić pierniczki artystyczne, jest na prawdę wiele!



Czy któraś z tych okazji jest dla niej naj wdzięczniejszym tematem do pracy? – Nie mam ulubionego motywu. Każdy cieszy mnie tak samo, ponieważ zawsze wkła dam tyle samo pracy i serca w ich reali zację – deklaruje. Inspirację czerpie czę sto z kolorowanek, książek i karuzeli dla dzieci. Projekty pierniczków powstają na życzenie jej klientów (kształty, wymiary, kolorystyka), ale jako ekspertka często pomaga im w stworzeniu konkretnej wi zji, proponując coś swojego, na co klienci chętnie przystają. Co ciekawe, stara się nie kupować goto wych foremek w sklepach, a projektuje własne! – Chciałam mieć coś swojego, nie
powtarzalnego, a przez to zupełnie innego od sklepowych „gotowców”. Foremki pro jektuję i wysyłam do realizacji do drukarni, z którą współpracuję od samego początku – mówi.
Znacząca część jej klientów, bo aż 90%, to osoby zamawiające pierniki online przez jej fanpage na Facebooku. Często z wysyłką za granicę, np. do Niemiec, Holandii, Austrii i Wielkiej Brytanii. Jej prace moż na także nabyć stacjonarnie przez odbiór osobisty prosto z pracowni. – Staram się wyjeżdżać 3-4 razy w roku na jarmarki dla rękodzielników i na mój ukochany fe stiwal, na który zawsze czekam, czyli Fe stiwal Czekolady z WeForm. To pozwala nie tylko sprzedać sporo pierników, ale daje możliwość bezpośredniego kontaktu z k lientem, nawiązania współpracy z in nymi rzemieślnikami. Jak sama przyznaje, najwięcej siły czerpie od zadowolonych klientów, którzy piszą, że pierniki od Piernikowej Mamy spełniają zarówno ich oczekiwania smakowe, jak i wizualne. – Klienci wybierają wzrokiem, bo piernik zawsze ma najpierw przykuć uwagę aspektami wizualnymi. Ale koniec końców jest przecież do zjedzenia. Dlatego staram się używać produktów najwyższej jakości, np. miód pochodzi od lokalnego pszczelarza, stosuję prawdziwe masło, cu kier trzcinowy. Nawet proszek do pieczenia mam eko.
Biszkopt czekoladowy (24 cm)
Masło 200 g Cukier (1) 150 g Żółtko 8
Czekolada gorzka 60% Bellaria 120 g Mąka pszenna 200 g Mąka ziemniaczana 60 g Proszek do pieczenia 15 g Białko 8 sztuk

Cukier (2) 50 g
Czekoladę rozpuścić w mikrofalówce. Masło utrzeć z cukrem (1) do puszystości. Żółtka dodawać co minutę, ubijając cały czas na średnich obrotach. Ubić białka z cukrem (2). Masę maślaną połączyć z czekoladą, następnie z suchymi składnikami. Dodać ⅓ ubitych białek i wymieszać, dodać resztę składników i ponownie wymieszać. Piec w 175°C przez 45 minut.
l e mon curd (dysk 21 cm)
Sok z cytryny 100 g Jajka 110 g Cukier 100 g Skórka z 2 cytryn Mąka migdałowa 50 g Masło 175 g
Pierwsze 4 składniki umieścić w misie robota i ubijać (85°C, obroty 3,5, czas 10 min). Dodać mąkę migdałową i zmiksować. Ostudzić do 45 stopni. Dodać masło, zblendować, a następnie wlać do ramki o śr. 21 cm. Zamrozić.
z łożenie
m us piernikowy

Przyprawa do piernika 15 g Czekolada mleczna 34,5% Bellaria 400 g Czekolada 60% Bellaria 50 g Ubita śmietana 305 g Zagotowana śmietana 325 g Żelatyna 8 g Woda 15 g
Żelatynę namoczyć w zimnej wodzie. Śmietanę zagotować z przyprawami, dodać do śmietany, następnie zalać nią czekoladę. Całość zblendować. Ostudzić do 35°C, wymieszać z ubitą śmietaną. Odstawić do lodówki.
Biszkopt przekroić na 3 plastry, pierwsze dwa przełożyć musem piernikowym, na wierzch włożyć cytrynowy dysk, pokryć warstwą musu i zamknąć trzecim biszkoptem. Przed wyciągnięciem z ramki zmrozić przez 15 minut. Gotowy tort udekorować resztą musu, plastrami pomarańczy lub cytryny, zmrożonymi owocami.
Spody piernikowe
Credin ciasto piernikowe 650 g Olej 135 g Jaja 135 g Woda 160 g Vortumnus powidła śliwkowe 270 g
Połączyć wszystkie składniki, mieszać płaskim mieszadłem przez 2 minuty na wolnych obrotach. Wylać do rantów i piec przez 30-35 minut w temp. 180°C.
n a dzienie
Vortumnus powidła śliwkowe 200 g Irca Toffee d’or Caramel 400 g Orzech włoski 200 g Orzech połówki 200 g
Wystudzone ranty przekroić na 2 części. Pierwszy blat przesmarować powidłami Irca Toffee d'or Caramel. Następnie wymieszać Irca Toffee d'or Caramel z orzechami i wyłożyć na powidła. Nałożyć połowę zrobionego wcześniej kremu orzechowego, przykryć drugim blatem i drugą połową kremu orzechowego. Wyrównać i schłodzić.

k r em orzechowy
Sonneveld Sonn Patis 1200 g Giuso pasta orzech włoski 300 g Woda 3000 g
Połączyć wszystkie składniki i ubijać przez ok. 5 minut.
p o lewa
Irca Mirabella Dark 600 g Orzech kawałki 100 g
Podgrzać polewę, dodać orzechy i oblać tort. Udekorować dekoracjami Dobla.



Lody czekoladowe to jeden z popularniejszych smaków. Najczęstszą wersją lodów „czekoladowych” są zaś te... kakaowe. Czym różnią się lody czekoladowe od kakaowych, co jeszcze można wyczarować z czekolady? Czytajcie dalej.
Lody kakaowe powstają z kakao. Różnią się od lodów czekoladowych ilością tłuszczu kakaowego, również smakiem no i oczy wiście kolorem. Lody kakaowe są zwykle ciemniejsze i bardziej „czekoladowe”. Kakao jest w pewnym sensie skompresowanym smakiem czekolady, ale brakuje w nim głębi uzyskiwanej dzięki tłuszczowi. Lody mlecz ne potrafią zrekompensować taką „pustkę” dzięki tłuszczowi. Dlatego lody kakaowe mogą być i najczęściej są smaczne oraz kojarzone z czekoladą mleczną.

Jak wspomniałem, lody czekoladowe zawie rają więcej tłuszczu kakaowego. Prowadzi to do problemów natury technologicznej, ponieważ nie powinno się dodawać ot tak czekolady do zbilansowanej bazy lodowej. Tym bardziej, jeżeli baza ta jest tłusta i za wiera sporo śmietanki. Może dojść wówczas do przedobrzenia z zawartością tłuszczów w lodach i w konsekwencji uzyskamy mało ciekawy, tłusty, niekoniecznie smaczny pro dukt. Dodatkowo tłuszcz kakaowy po za mrożeniu powoduje twardnienie lodów, co piętrzy trudności przed rzemieślnikami.
Lody czekoladowe powinny być co do zasady zbilansowane osobno. Baza czekoladowa musi uwzględniać dodatkowy tłuszcz uzyska ny z czekolady, tak aby zarówno smak, jak i twardość produktu końcowego były satysfakcjonujące.








Najczęściej pojawiają się pytania, co robić z czekolady? Odpo wiedź jest prosta. Co tylko dusza zapragnie. Smaki czekoladowe to m.in. gianduia (nutella); kinder joy, kinder bueno (biała cze kolada i orzech laskowy), czekolada ciemna, mleczna i biała oraz wszystko, co można na bazie tych czekolad stworzyć. Szczególnie wdzięczne są połączenia czekolad z orzechami. Warto inspirować się gotowymi popularnymi produktami i połączeniami smaków mi strzów czekolady, warto zaglądać i obserwować czekoladowych mistrzów, odtwarzać ich ganasze i kompozycje w lodach. Czy próbowaliście już połączenia czekolady z rozmarynem, wędzoną śliwką, serem cheddar lub różą i pistacją? Równie wdzięczne są połączenia z owocami. Szczególnie upodo bałem sobie łączenie czekoladowych lodów mlecznych ze słod kimi owocami, takimi jak: mango, banan, brzoskwinia, wiśnia, malina i truskawka, oraz sorbetów czekoladowych z cytrusami: kalamansi, marakują, limonką czy grapefruitem.


Aby uzyskać czekoladowy smak lodów wystarczy już 10-12% czekolady w składzie lodów mlecznych. Często, jeżeli mamy już skomponowaną recepturę na lody czekoladowe, możemy zamie niać część czekolady na orzechy (w formie pasty 100%). Zarówno najpopularniejsze czekolady, jak i orzechy mają zbliżone proporcje tłuszczu. Minusem stosowania czekolady bez kakao w recepturze jest kolor – daleki od ciemnoczekoladowego. Osobiście polecam uzupełnić recepturę o kakao lub miazgę kakaową, taki dodatek wzmocni wrażenia smakowe i kolorystyczne. Jeżeli chodzi o sorbety czekoladowe, to należy pamiętać, że warto wykorzystać absolutne maksimum tłuszczu kakaowego w bilan sie receptury. Dzięki temu uzyskamy odpowiednią smarowność i konsystencję zbliżoną do smaków lodów mlecznych. W przypad ku sorbetów nie ma potrzeby dodawania kakao. Lody na bazie czekolady są ciemne i prawdziwie czekoladowe.


Rajmund Kawalec, Kames Zaangażowany w lodziarstwo od końca lat 80. XX w., zaczynał od pierwszej polskiej agencji firmy Carpigiani. Od roku 1991 związany z Kames – firmą specjalizującą się w zaopatrzeniu lodziarzy rzemieślników. Początkowo jako konsultant i technolog, od 2004 kieruje firmą. Autor i redaktor wielu materiałów związanych z lodami, dostępnych w prasie branżowej i we własnych zasobach Kames https://www.kames.pl

Do niedawna szyldzik z nazwą „czekoladowe” przeciętnemu polskiemu konsumentowi kojarzył się z dość łagodnym, typowym smakiem kakao z mlekiem. Jednak rynek produktów z kakao stale się rozwija, więc mamy coraz większy wybór czekolad o różnej zawartości kakao, z różnych regionów świata i od coraz większej liczby producentów. Umożliwia to tworzenie coraz to nowych kompozycji, popyt na nie stymulują także konsumenci, którzy pytają o smaki, z jakimi zetknęli się podczas wakacyjnych wyjazdów lub w mediach.

Kakao sprowadzane jest z rejonów dość egzotycznych. Wenezuela, Do minikana, Ekwador, Meksyk, Gwate mala, Madagaskar, Kuba, Uganda i Sao Tome to nazwy, które kojarzą się właśnie z wakacjami czy przygodą – nawet tym, których nie stać na takie eskapady. Stosując jedną recepturę, można robić coraz to nowe lody czekoladowe, wprowadzając kakao w proszku, czekoladę czy miazgę o konkretnym pochodzeniu i podkreślając to w nazwie.
Ma to szczególne znaczenie zimą, kiedy wiele lodziarni (oczywiście mowa o tych działających przez cały rok) ogranicza asortyment lodów owocowych, zastępując je smakami „cieplejszymi”, opartymi na mleku, kakao lub orzechach. Z racji tego wprowadzenie do oferty kilku wa riantów lodów czekoladowych jednocześnie jest zabiegiem wygodnym, a jednocześnie intrygującym dla konsumentów.

Oprócz typowych smaków lodów czekoladowych – z czekolady mlecznej i ciemnej – pro dukty z kakao wykorzystywane są do tworzenia wielu lodowych kompozycji, mogą być zarówno ich głównym składnikiem, jak i tylko tłem dla innych smaków.


Ciemna czekolada doskonale komponuje się z orzechami. Do klasyki należy połączenie z orzechem laskowym, nazywane we Włoszech gianduia i znane tam co najmniej od końca XVIII w. Ciekawostką jest, że smak ten powstał w północnych Włoszech w wyniku trudności w dostawach kakao, kiedy jego brak próbowano częściowo zastąpić łatwo dostępnym surowcem lokalnym – pastą z orzecha laskowego. Przyniosło to spektakularny sukces. Lody gianduia można zrobić z mieszanki pod stawowej i pasty gianduia (mieszanki kakao i orzecha laskowego w proporcji ok. 2:1) – oferowanej w różnych odmianach przez większość włoskich dostawców. Jest to sposób najpo pularniejszy, bo najprostszy. Warto pamiętać o dodatku glukozy i wody w celu poprawienia bilansu mieszanki.
Lody czekoladowe
Rec. 9
SkładnikIlośćCukierTłuszczSSBMISSRSS
Mieszanka podstawowa 1,000,180,060,100,020,35 Pasta gianduia 0,08 0,04 0,040,08 Glukoza krystaliczna 0,050,05 0,05 Woda0,06
RazEM1,190,220,100,100,06 0,47 18,7%8,2%8,1%4,9%39,8%
Nieco ambitniejsze podejście będą reprezentować ci, którzy zrobią lody gianduia w oparciu o jedną z poprzednio podanych re ceptur na lody czekoladowe, np. rec. 7 („MB” październik 2022), w której część produktów kakaowych zastąpią pastą z orzecha laskowego (100%).
Rec. 10
SkładnikIlośćCukierTłuszczSSBMISSRSS
Mleko 3,2% tłuszczu 1,000 0,0320,0800,0200,132 Cukier (sacharoza) 0,2200,220 0,220 Glukoza krystaliczna 0,0700,064 0,064 Czekolada ciemna 60% kakao (8323) 0,0800,0310,0260,0200,078
– cz.2 Lody Mistrz

Nazwa „lody czekoladowe” zazwyczaj kojarzy się z produktem o wyraźnym smaku kakao i w kolorze typowej tabliczki. Można jednak zrobić pełnoprawne lody czekoladowe z czekolady białej, na przykład według następującej receptury:
SkładnikIlośćCukierTłuszczSSBMISSRSS Woda 1,00 Biała czekolada 30% masła kakaowego 0,38 0,140,14 0,08 0,37 Cukier (sacharoza) 0,150,15 0,15 Mleko w proszku odtłuszczone 0,08 0,070,010,08 Syrop glukozowy DE38 w proszku 0,060,02 0,040,06 Baza 5 g0,006 0,010,01 RazEM 1,6760,32 0,14 0,150,050,66 18,9%8,6%9,0%3,0%39,6%
Jeśli przygotowujemy taką mieszankę poza pasteryzatorem, trzeba ją podgrzać, stale mieszając, do temperatury ok. +85ºC – czeko ladę dodajemy dopiero po podgrzaniu pozostałych składników. Całość należy starannie zmiksować i odstawić, a zamrażać, gdy ochłodzi się do +50ºC1 (ok. 1 h). W takich lodach jedynym surowcem „czekoladowym” jest masło kakaowe, więc nie powinny sprawiać szczególnych kłopotów przy sprzedaży, jeśli łączną zawartość tłuszczu w recepturze utrzyma my poniżej 8-9%. Nie potrzeba też dodawać do nich alkoholu, chyba że zależy nam na konkretnym efekcie smakowym – masło kakaowe świetnie łączy się z rumem, whisky i innymi alkoholami2. Lody z białej czekolady będą oczywiście wyglądać jak zwykłe lody śmietankowe3, ale jeśli użyjemy do nich dobrej jakości czekola dy, klienci z pewnością to docenią. Jej delikatny smak doskonale komponuje się z niemal wszystkimi owocami, z racji tego lody te są znakomitą bazą do kompozycji przekładanych owocowy mi pastami variegato, gotowymi lub własnego wyrobu, ale nie tylko. Dobrym dodatkiem do białej czekolady będą także pasty orzechowe – można postąpić jak w przypadku smaku gianduia, zastępując część dozy czekolady pastą orzechową lub pistacjową, np. jak w recepturze 12.
Rec.12
SkładnikIlośćCukierTłuszczSSBMISSRSS
Woda1,000 Biała czekolada 30% masła kakaowego 0,2800,1060,1060,0600,0030,274
Cukier (sacharoza) 0,1600,160 0,160 Pasta pistacja 100% 0,1200,0050,0670,0450,118 Glukoza krystaliczna 0,0600,055 0,055
Mleko w proszku odtłuszczone 0,060 0,0530,0050,058 Baza 5 g0,006 0,0060,006 RazEM 1,6860,326 0,173 0,1130,0590,671 19,34%10,26%6,70%3,50%39,80%
Warto przypomnieć, że w czasach przed bazami, gdy lody mleczne były robione na żółtkach, lody czekoladowe także je zawierały. Charakterystyczny smak żółtek jest doskonałym uzupełnieniem dla czekolady – niektórzy nie wyobrażają sobie lodów czekoladowych bez tego dodatku. Poniżej przykładowa receptura, w której wykorzystano żółtka.
SkładnikIlośćCukierTłuszczSSBMISSRSS
Mleko 3,2% tłuszczu 0,9000,0290,0720,0180,119 Cukier (sacharoza) 0,1900,190 0,190 Czekolada ciemna 60% kakao 0,1600,0620,0530,0400,155 Woda0,100 Kakao 22/240,070 0,0160,0530,069 Żółtko 0,0700,0220,0130,035 Glukoza krystaliczna 0,0600,055 0,055 Baza 5 g0,004 0,0040,004 RazEM 1,5540,3070,1200,0720,1280,627 19,76% 7,72% 4,63%8,24%40,36%
Żółtka mają wpływ nie tylko na smak, ale też na strukturę lodów, a to ze względu na zawartość tłuszczu i białek oraz naturalnego emulgatora – lecytyny (która jest obecna w większości czekolad).
Owoce można połączyć z czekoladą nie tylko w postaci variega to. Atrakcyjny efekt osiągniemy także, używając owoców jako składnika mieszanki. Ponieważ czekolada ma dość zdecydowany smak, najlepiej nadają się do tego owoce o wyrazistym, mocnym aromacie. Dobrym wyborem jest np. mango. Poniżej ciekawa receptura, w której wykorzystano niesłodzoną pulpę z tego owocu.
Rec. 14
SkładnikIlośćCukierTłuszczSSBMISSRSS
Mleko 3,2% tłuszczu 1,000 0,0320,0800,0200,132 Mango pulpa 10% cukru 0,3700,037 0,0190,056 Czekolada ciemna 60% kakao 0,2500,0970,0920,0600,248 Cukier (sacharoza) 0,2200,220 0,220
Śmietanka 36% tłuszczu 0,120 0,0430,0070,050 Syrop glukozowy DE 38 w proszku 0,0750,029 0,044 0,073 Inulina0,0300,002 0,0280,030 Glukoza krystaliczna 0,0250,023 0,023 Baza 5 g 0,006 0,0060,006 RazEM2,0960,4080,1670,0870,1770,838 19,5%8,0%4,2%8,4%40,0%
Dodatkowym atutem łączenia owoców z czekoladą jest prawo do nazwania takich lodów zarówno czekoladowymi, jak i owocowy mi, bo mają zauważalną zawartość obu składników. W receptu rze 14 mamy 12% czekolady i 18% owoców, możemy więc legalnie użyć apetycznie brzmiących nazw, jak czekolada z mango, mango z czekoladą czy czekoladowe mango. Przy owocach o mniej zdecydowanym smaku, jak śliwka, czy gruszka, warto rozważyć połączenie z czekoladą mleczną. Możemy także wybrać moment dodania owoców do mieszanki. Jeśli całość przygotujemy na gorąco, efekt będzie zupełnie inny, niż gdy dodamy je dopiero po schłodzeniu mieszanki. Ponadto gdy wykorzystujemy owoce nieprzetworzone, a nie pulpę, po ich dodaniu musimy mieszankę starannie zmiksować.
Stosowanie przypraw do lodów czekoladowych jest bardzo pro ste – wystarczy je dodać do mieszanki lub posypać gotowe lody. Sztuka polega na tym, by, po pierwsze, dopasować przyprawę do rodzaju lodów czekoladowych. Nie ma tu bezwzględnych reguł, ale warto trzymać się zasady, że im mocniejszy smak przyprawy, tym intensywniejszy powinien być smak lodów, które chcemy nią „przyprawić”. Na przykład modne ostatnio chili czy klasyczny imbir sprawdzą się w czekoladach wytrawnych, kardamon i cy namon – w mlecznych.
Po drugie, trzeba dobrać odpowiednią dozę przyprawy, co wymaga eksperymentów. Ważne jest, by przeprowadzić testy na większej liczbie osób – im więcej ich będzie, tym szerzej akcep towany będzie rezultat.
Oprócz gotowych przypraw można wykorzystywać własnoręcznie przygotowane napary, wywary lub maceraty – z ziół i roślin przyprawowych, wykorzystując do tego wodę lub mleko użyte w recepturze.
Lody z widocznymi mniejszymi lub większymi kawałkami czeko lady4 w masie stały się dość popularne. Można wyróżnić trzy kla syczne techniki ich przygotowania, które stosuje się w zależności do upodobań i posiadanego sprzętu:
Roztopioną czekoladę wylewa się cienką warstwą na silikonową matę lub pergamin, następnie wkłada do szafy mroźniczej. Gdy dobrze stwardnieje, łamie się ją na kawałki i wsypuje do frezera pod koniec zamrażania, kiedy lody są prawie gotowe. W t ym celu najlepiej zatrzymać na chwilę maszynę, otworzyć klapę cylindra i wsypać przygotowaną czekoladę, następnie za-
mknąć klapę i kontynuować zamrażanie. Jeśli posiadamy frezer pionowy, sprawa jest prostsza – można łatwo wsypać czeko ladę do cylindra, nie wyłączając maszyny. W obu przypadkach moment wrzucenia wybiera się doświadczalnie, pamiętając, że im dłużej czekolada będzie kręcona razem z lodami, tym mniejsze staną się jej kawałki, pokruszone przez mieszadło. W przypadku frezera pionowego można wlewać roztopioną cze koladę (w najniższej temperaturze, w której stanie się płynna) do zbiornika maszyny pod koniec zamrażania. W zależności od momentu i techniki można uzyskać inne efekty. Czekoladę można dodać do gotowych lodów podczas wydawa nia z frezera – raczej poziomego, bo przy pionowym wygodniejszy jest poprzedni sposób. Roztopioną czekoladą (w najniższej temperaturze, w której stanie się płynna) polewa się kolejne warstwy lodów układane w kuwecie – dwie, trzy lub więcej. Następnie energicznymi ruchami łopatki przebija się je, krusząc zestaloną w międzyczasie czekoladę na mniejsze lub większe kawałki. Jeżeli chodzi o samą czekoladę, to na ogół jest ona produktem opracowanym specjalnie dla lodów stracciatella, w którym masło kakaowe zostało częściowo lub całkowicie zastąpione tłuszczem kokosowym. Potrzeba takiej modyfikacji wynika ze stosunkowo wysokiej temperatury topnienia masła kakaowego – ok. +35ºC. Ta cecha powoduje, że kawałki czekolady znajdujące się w lodach sprzedawanych z witryny lub kontuaru, a więc w temperaturze ok. 10ºC, po dostaniu się do ust długo pozostają nieprzyjemnie twarde i zimne. Po wymianie tłuszczu na np. kokosowy, którego temperatura topnienia jest dużo niższa (ok. +25ºC), tak zmodyfikowana czekolada topi się szybciej, dzięki czemu wydaje się cieplejsza5 i niemal od razy wyczuwamy jej smak. Klasyczną wersję stracciatella robi się z lodami śmietankowymi, ale często spotyka się kompozycje z lodami miętowymi, kokosowymi i o innych smakach – także czekoladowymi, w których kawałki czekolady dodatkowo akcentują smak i charakter lodów.
Dotyczy przede wszystkim lodów na patyku, ale często oblewane są także te z automatu. Z reguły stosuje się te same polewy co do lodów stracciatella, chociaż do oblewania obu tych rodzajów można również użyć zwykłej czekolady. Przy oblewaniu lodów ważne jest uzyskanie możliwe cienkiej warstwy polewy. W przypadku lodów na patyku jest to łatwiejsze, bo oblewa się je, kiedy mają temperaturę nawet znacznie poni żej -20ºC. Dzięki temu można ogrzać czekoladę do temperatury, w której stanie się na tyle płynna, że wystarczy bardzo krótkie zanurzenie w niej loda, by pokrył się polewą, błyskawicznie tężejącą w zetknięciu z jego mocno zamrożoną powierzchnią. Uzy skanie cienkiej warstwy polewy daje dwie korzyści. Jedną jest oszczędność, bo zużywa się mniej polewy. Drugą, równie ważną, jest komfort jedzenia – cienka polewa łatwiej poddaje się gryzieniu, nie odpada i szybciej topi się w ustach, nie powodując nieprzyjemnego odczucia zimna – nawet gdy jest to prawdziwa czekolada, bez tłuszczu kokosowego. Lody z automatu są oblewane czekoladą w temperaturze serwo wania. Na ogół jest to ok. -6ºC (świderki ok. -9ºC), więc w momencie oblewania są znacznie cieplejsze od lodów na patyku.
Z tego powodu łatwiej oblewać je polewą zmodyfikowaną tłusz czem kokosowym, która staje się wystarczająca płynna w dużo niższej temperaturze niż czekolada. Najbardziej rozpowszechnioną techniką oblewania lodów jest maczanie w czekoladzie ogrzanej do potrzebnej temperatury w pod grzewaczu z termostatem. Znacznie bardziej widowiskowe jest oblanie porcji lodów, a także waflowego rożka (przed nałożeniem lodów) przy użyciu podgrzewacza wyposażonego w pompę, podającego podgrzaną czekoladę przez wylewkę umieszczoną nad zbiornikiem. Dodatkową atrakcją jest nieprzerwanie płynąca z niej strużka czekolady, która ładnie pachnie i zwraca uwagę klientów. To rozwiązanie jest popularne we Włoszech i wielu krajach zachodniej Europy, powinno więc przyjąć się także w Polsce, gdzie na razie jest niemal nieznane.
Prażone i pokruszone na drobne kawałki ziarna kakao, nibsy, oferuje wielu producentów czekolady. Jeśli są delikatne i kruche, będą znakomitym dodatkiem do lodów. Jednym z ciekawszych zastoso wań jest dodanie ich do lodów czekoladowych, w których, mimo że z racji koloru są prawie niewidoczne, wprowadzają przyjemny efekt chrupania oraz nutę wytrawnego kakao. Przed użyciem warto sprawdzić, czy nibsy są dobrze oczyszczone z łupin zia ren – ich okruchy są bardzo twarde i nie nadają się do jedzenia.
lody czekoladowe w witry Nie lub koNtuarze Lody czekoladowe mają zwykle wyższą temperaturę topnienia, a t ym samym wyższą temperaturę serwowania niż pozostałe lody w witrynie czy kontuarze. Jest tak zwłaszcza wtedy, gdy użyto źle zbilansowanej receptury, co zdarza się dość często. W takiej sytuacji, aby uniknąć walki z twardymi jak kamień lodami, reme dium jest znalezienie w witrynie lub kontuarze najmniej zimne go miejsca i umieszczenie tam kuwety z lodami czekoladowymi. Niezależnie od receptury, w miarę upływu czasu lody czekoladowe w kontuarze czy w witrynie będą twardnieć – tym bardziej, im większy jest w nich udział kakao w proszku lub miazgi kakaowej. Głównym sposobem przedłużenia stabilności ich konsystencji jest staranne przygotowanie mieszanki – w procesie gorącym, z emul syfikacją i jak najdłuższym dojrzewaniem.
1 Nie należy zostawiać mieszanki na dłużej, ponieważ po ochło dzeniu poniżej +45ºC będzie stanowić środowisko sprzyjające rozwojowi bakterii groźnych dla człowieka.
2 Dodając alkohol, na wszelki wypadek warto trzymać się zasady, by jego zawartość w gotowych lodach nie przekroczyła 1,2%. Co prawda lody nie są wyrobem objętym akcyzą, ale szukający wpływów fiskus jest nieprzewidywalny.
3 Chyba że użyjemy czekolady z dodatkiem naturalnej wanilii, wtedy w lodach widoczne będą jej czarne nasionka.
4 Stracciatella z wł. „stracciare” – rwać na kawałki.
5 Dotyczy to również lodów, w których część lub całość tłuszczu mlecznego (temperatura topnienia ok. +38ºC) zamieniono na tłuszcz kokosowy.





















Smart Factory (Inteligentna Fabryka) staje się rzeczywistością. Wdrożono ją w wielu przedsiębiorstwach, także w branży piekarskiej i cukierniczej. Kto na bieżąco śledzi nowoczesną produkcję piekarską i cukierniczą, ten widzi automaty produkcyjne, pracowników z mobilnymi narzędziami i magazyny, które organizują się same. Roboty przemysłowe przejmują coraz więcej zadań, także czujniki – baza usieciowionej produkcji – stają się coraz lepsze.

Adam Steć członek zarządu CSB-System Polska Sp. z o.o.


Współcześnie każda inwestycja w przemyśle piekarskim i cukierniczym musi prowadzić do Smart Factory. Tylko konsekwentna cyfryzacja pozwala na skuteczne podej mowanie takich wyzwań, jak: elastyczność, przejrzystość, indy widualizacja i wysoka efektywność.
Roz WIą zanIa do automatyzacjI inteligentne urządzenia produkcyjne i maszyny
Jednym ze składników sukcesu w Smart Factory są nowoczesne rozwiązania automatyki przemysłowej. Na rynku funkcjonuje wiele obiecujących rozwiązań, ale największy potencjał drzemie obecnie w logistyce wewnętrznej. W przemyśle spożywczym wiele maszyn, takich jak: zautomatyzowane urządzenia produkcyjne i pakujące częściowo zautomatyzowane systemy kompletacji, automatyczne urządzenia do paletyzacji, urządzenia sortujące oraz magazyny
wysokiego składowania dla palet lub pojedynczych pojemników, należą już do standardowego repertuaru przedsiębiorstw. To prak tyczne rozwiązania gwarantujące optymalną realizację wyzwań, tj. zwiększający się asortyment, wahająca się sprzedaż oraz krót kie czasy zamówień i dostaw.
Automatyzacja a kompleksowy łańcuch produkcyjno-logistyczny Rozwiązania automatyki stają się zasadniczym elementem Smart Factory dlatego, że w połączeniu z wydajnym system IT realizu ją bardzo wymagające procesy w obszarze produkcji i logistyki. Automatyzacja na poziomie hali produkcyjnej zrobiła duży krok naprzód, wiele systemów może mniej lub bardziej samodzielnie realizować kompleksowy łańcuch procesowy, np. przy tzw. casy calculation, która podczas przygotowania kalkulacji dzieli zlecenia klienta na zoptymalizowane pod kątem napełnienia opakowania. Na tej podstawie, sterując zleceniami z poziomu IT, można opty malnie przydzielić potrzebne ilości na linie pakujące i sortujące. Efektem jest opracowanie bardzo dużej ilości danego artykułu. Inteligentne koncepcje automatyzacji wyróżniają się przede wszystkim dzięki:
1. Właściwemu zastosowaniu: podczas opracowywania rozwią zania dotyczącego automatyzacji wielkość przedsiębiorstwa, kubatura i uwarunkowania budowlane są ważnymi parametrami, które należy uwzględnić w trakcie opracowywania procesów.
2. Inteligentnej infrastrukturze automatyki: technika magazynowa i kolejkowa, która może w czasie rzeczywistym rejestrować i przesyłać dane przez technologię identyfikacji, technikę sen soryczną albo nawet robotykę.
3. Rozwiązaniom software’owym dla płynnej komunikacji między niezależnymi systemami. Zaliczają się do nich głównie syste my MES, sterowania, a przede wszystkim systemy ERP. Tym samym można już istniejący sprzęt, jak starsze maszyny albo magazyny wysokiego składowania, zintegrować i przygotować do cyfrowej transformacji. Technologia informatyczna, urządzenia produkcyjne, a także robo tyka coraz bardziej przenikają się, co wspiera opłacalność produkcji mniejszych ilości. Zwłaszcza przy niskich marżach albo wysokiej presji cenowej połączona w sieć automatyzacja produkcji, pako wania, magazynowania i kompletacji oferuje najlepszą strategię pozwalającą na obniżenie kosztów i poprawę zdolności do kon kurowania na rynkach.
PR zemyS łoWa analIz a obR a zu twoja Fabryka może widzieć W Smart Food Factory nie chodzi tylko o rejestrację i opra cowanie danych. Kto bezpośrednio analizuje dane w procesie i automatyzuje sortowanie surowców albo produktów goto wych, ten rzeczywiście wykorzystuje potencjał danych. Kluczo wą technologią jest przemysłowa analiza obrazu. Gwarantuje ona wiele korzyści tam, gdzie ludzkie oko napotyka na grani ce podczas pomiarów. Przemysłowa analiza obrazu umożliwia szybkie oceny dobrze/źle podczas kontroli jakości, rozpoznaje deformacje lub ciała obce. Przemysłowa analiza obrazu zawiera trzy innowacje:
1. Bezpośrednio podczas przyjęcia można sklasyfikować surosu rowce według celu zużycia. Decydujące są przejścia do sys temów nadrzędnych. W sytuacji kiedy system przesyła dalej wyniki pomiaru albo błędy, sterowanie urządzeniami może posłać surowce do właściwego magazynu. Oprogramowanie ERP inicjuje również automatyczną ocenę dostawców i daje obszarowi zakupów najważniejsze dane do dyspozycji.
2. Podczas wyjścia towaru każdy półfabrykat albo produkt pod lega ocenie nie ludzi, a dzięki dokładnemu obrazowi z kamery. Ten zautomatyzowany proces gwarantuje wyższą wydajność operacyjną, w związku z czym istotnie spada liczba błędów, a pracownicy są wolni od monotonnych zadań.
3. Technologia ta osiąga dużą wydajność przy rozpoznawaniu pojemników/opakowań. W ten sposób można szybko i auto matycznie zarejestrować puste pojemniki zwrotne: identyfi kacja, liczenie, dokumentowanie – wszystkie te kroki robocze można zrealizować z pomocą analizy obrazu i bez ręcznego nakładu pracy.
SyStemy zaR z ądzanIa – wykorzystywanie danych z maszyn
Smart Food Factory osiąga wydajność operacyjną również dzięki przewidującemu sterowaniu oraz serwisowaniu procesów i ma szyn. Wyposażenie urządzeń w punkty sensoryczne i zintegro wane jest sprawą zasadniczą. Należy także cyfrowo rejestrować parametry procesów poprzedzających, agregować je, analizować i udostępniać produkcji. Dane są bazą analitycznych rozwiązań
software’owych, informacji o wydajności danej maszyny, proce sów albo całych cykli produkcyjnych.
Ta baza danych pozwala na rozpoznanie korelacji między awariami maszyn i parametrami obciążenia. Prace serwisowe można wy konać na czas i zgodnie z planem, co eliminuje kosztowne prze stoje. Można uchwycić kolejne zdarzenia, które mają negatywny wpływ na efektywność maszyn (OEE), tj.: dostawa półproduktów niedostrojona do maszyny, nieskoordynowane przerwy albo nie równomierne obłożenie maszyn.
Coś więcej niż krótkotrwałe, częściowe optymalizacje procesów Niektóre zakłady piekarskie już wykorzystują potencjał danych z maszyn, np. identyfikują przestoje urządzeń i rozpoznają, czy pracownicy dostatecznie szybko reagują albo podają informację o zmianach, na których często dochodzi do wyłączeń lub awarii. Wydajne rozwiązanie do serwisowania charakteryzuje się nie tylko zdolnością do pozyskania danych historycznych o stanie maszyn, powinno także zadbać o ekspozycję adekwatnych informacji w do stępnej formie w odniesieniu do procesu i struktury organizacyj nej. Zarejestrowane dane o stanie maszyn, zużyciu i o awariach muszą być dostępne zarówno przy maszynie, jak i w biurze. Tylko tak otrzymuje się kompleksową analizę urządzeń i dokumentację w czasie rzeczywistym.
Web & cloud aPPS – pomost między produkcją a zarządzaniem Sztuczna inteligencja i samouczące się systemy będą odgrywać w branży piekarskiej i cukierniczej coraz większą rolę. Obecnie potrzebujemy przede wszystkim stałego przepływu danych i in formacji w celu podejmowania właściwych decyzji o sterowaniu przemysłowym przepływem wartości. Centralne udostępnienie tych informacji jest elementem decydującym o sukcesie. Aplikacje Web czy bazujące „na chmurze” kontrolują i sterują całym procesem produkcyjnym i dostarczają dashboardów dla danych przedsiębior stwa, sprzedaży albo wskaźników o produkcji i rentowności na PC, tabletach czy smartfonach. Ważne informacje są generowane i udo stępniane tam, gdzie odbywa się tworzenie wartości i gdzie są po trzebne: na przyjęciu surowców, w produkcji, podczas kompletacji. Mobilny dostęp do ważnych danych umożliwia ponadto analizę procesów operacyjnych niezależnie od miejsca. Aktualne wskaź niki, informacje o trendach rynkowych, o produkcji i scenariusze biznesowe są dostępne non stop na miejscu u klienta albo pod czas podróży służbowej.
Podejmowanie szybkich decyzji dzięki cyfrowemu wsparciu Monitoring online sprosta największym wyzwaniom rynkowym. W branży cukierniczej nawet najmniejsze cyfry mają znaczenie. Nieznaczne odchylenia, np. przy cenach dziennych zakupu surow ców, mogą oddziaływać na ostateczny wynik przedsiębiorstwa. Badania i opracowania potwierdzają, że mobilny dostęp do ana liz jest głównym wymaganiem stawianym systemom IT. Ten, kto ponosi odpowiedzialność, chce być zawsze na bieżąco z infor macjami. Nowoczesne WEB Apps stają się asystentami zarządu, dbają o daleko idącą przejrzystość danych, które są opracowane i przedstawiane w wybranej przez użytkownika formie.
To pytanie spędza sen z powiek wielu polskim przedsiębiorcom. Dlaczego właściwie Polacy wolą pójść w jedno miejsce, w którym mogą dość szybko zrobić kompleksowe zakupy podstawowych produktów spożywczych, chemii czy artykułów gospodarstwa domowego?
Odpowiedź jest bardzo prosta to po prostu wygodne. Jeste śmy dość zabiegani, zapracowa ni i zajęci, dla dużej części społeczeństwa taki rodzaj zakupów jest rozwiązaniem naj prostszym. Nie zastanawiamy się nad tym, jakie konsekwencje niesie ze sobą wybór marketów jako stałego miejsca zakupów. Czy właśnie nie na tym polega problem? Może więc i rzemieślnicy powinni posze rzać swoją ofertę o inne, ciekawe produkty spożywcze.
Piekarnie i cukiernie to przecież miejsca, gdzie produkuje i sprzedaje się żywność. Markety są bezpośrednią konkurencją ta kich placówek handlowych, zatem klienci, w naturalny sposób trafiając do marketu, często kupują też pieczywo, ciasta itp. Tak przy okazji, nie zastanawiając się nad tym. Właściciele piekarni i cukierni mogą postę pować analogicznie, a więc produkować: świeży makaron, garmaż, pierogi, soki, napoje, sałatki, kanapki, dżemy, konfitu ry, przetwory warzywne, świeże warzywa i owoce, dania obiadowe, cukierki, czeko ladki, chipsy owocowe, kawy, herbaty czy lody na wynos. Jak widać, możliwości jest wiele, tylko od właściciela i dostępnej prze strzeni zależy to, jakie artykuły znajdą się w punkcie sprzedaży. Ważne jest jednak, aby stoiska były tematyczne, a towar nie był ze sobą mieszany.


Zadajmy sobie zatem pytanie: mamy pro dukować wszystko? Nie, nie można tego ro bić i wcale nie trzeba. Rozwiązaniem może być połączenie sił z innymi rzemieślnikami z regionu, w czym pomoże Stowarzysze nie „Rzemieślnik”. Budujemy społeczność rzemieślników, miejsce, w którym będzie my kojarzyć ze sobą potrzeby i możliwości. Oczywiście można to również osiągać na własną rękę, ale w gąszczu codziennych spraw brakuje czasu na takie rozwiązania. To propozycja na miarę naszych czasów, ponieważ ścisła współpraca pomiędzy rze mieślnikami jest dziś jedyną drogą do za chowania i wzmocnienia tej części branży, która chce się zrzeszać, rozwijać. Poszerzenie asortymentu to naturalna kolej rzeczy w handlu, obserwujemy to na sta cjach benzynowych, w sieciach sklepów
osiedlowych, model convenience store ist nieje na świecie już od lat 70. XX w. Dla czego powinniśmy dostosować się do reguł, które już panują na rynku? Ponieważ istnie je tu sporo miejsca na kreatywność. Jeśli nasza piekarnia czy cukiernia radzi sobie całkiem dobrze, możemy zaskoczyć klien tów następnymi produktami rzemieślniczy mi na równie wysokim poziomie. Właśnie ta najwyższa rzemieślnicza jakość, świeżość, lokalność, poziom obsługi stanowi przewa gę nad „Lidronkami”. Sieci handlowe mają również swoje problemy, takie jak: skomplikowana logistyka; długofalowe planowanie asortymentu, problematyczne przy zmieniających się cenach; trudności w sprzedaży produktów szybko psujących się;
 Mirosław Kurek
Mirosław Kurek
problemy z rozkładaniem towarów za mało pracowników;
niska jakość obsługi wynikająca również ze zbyt małej liczby pracowników; fale zakupowe, problem z obsadzeniem odpowiedniej liczby stanowisk kaso wych itp.
Rzemieślnicy ze względu na małą skalę działania są w stanie znacznie szybciej re agować na potrzeby rynku, mają szansę, by zapewnić znacznie wyższą jakość, wszyst kie produkty mogą mieć czyste etykiety. Możemy sprawić, że nasze punkty sprze daży będą również coraz wygodniejszymi miejscami codziennych zakupów. To silne strony zakładów rzemieślniczych, które dają przewagę nad marketami. Odnoszę wrażenie, że przedsiębiorcy z branży piekarskiej, cukierniczej skupili całą swoją uwagę i energię na tym, aby konkurować z marketami w jednej kwestii, a mianowicie cen. Nie tędy droga. Jedyną konkurencję, w której możemy wygrywać, stanowi rzemieślnicza jakość, ponieważ to coś, czego fabryki nie mogą osiągnąć ze względu na skalę produkcji. Niewielka skala działalności to coś, co również nale ży pokazywać klientom, z czego powinna wynikać przewaga rzemiosła nad sieciami handlowymi. Robiąc zakupy w sklepach wielkopowierzchniowych, nie wiemy ani kto, ani gdzie, ani z czego wyprodukował pieczywo, w przeciwieństwie do małych zakładów, gdzie klient może dowiedzieć się wszystkiego, czasem nawet porozmawiać z piekarzem.
Nic nie stoi na przeszkodzie, aby polscy przedsiębiorcy również mogli uruchamiać nowoczesne placówki handlowe zoriento wane na cały przekrój oferty spożywczej, z tą różnicą, że zrobią to lepiej, a sprzeda wać będą wyłącznie wyroby rzemieślnicze, ekologiczne, lokalne, organiczne, z czystą etykietą itp.
To sprawi, że na rynek wróci równo waga, która została bardzo mocna za chwiana. Nikt nie zapanował nad de gradacją polskiego handlu i likwidacją małych polskich punktów sprzedaży. Te ostatnie też nie mają wielkich szans na przetrwanie z u wagi na to, że oferu ją podobne produkty jak markety, ale zwykle drożej. Owszem utrzymały się jeszcze specjalistyczne sklepy mięsne, warzywniaki czy sklepy rybne, ale sta ło się tak właśnie dlatego, że odbiegają ofertą od marketów.
Jak już wspominałem, wybierając na za kupy markety, wpływamy na kilka kwestii. Wspieramy wielkie ubojnie, fermy drobiu, zakłady przetwórstwa itp., a tam ze wzglę du na skalę produkcji nie można pozyskać wysokiej jakości mięsa. Warzywa i owo ce zwykle pochodzą z wielkich zagranicz nych plantacji, przyjeżdżają do kraju nie do końca dojrzałe, są pakowane w folię. Pieczywo oferowane w sklepach wielko powierzchniowych produkuje się na dużą skalę w fabrykach zlokalizowanych wiele kilometrów od miejsca sprzedaży, z wysoko przetworzonych surowców, nie zachowując tradycyjnych, rzemieślniczych procesów. Podsumowując, nasze wybory są powo dem wzrostu powierzchni monokultur rolniczych, użycia nawozów sztucznych, zwiększania śladu węglowego produktów czy ilości odpadów. Natomiast rzemieśl nicze sklepiki, oferując żywność wysokiej jakości, wspierają lokalną społeczność, biz nes, zatrudnienie, polskie rolnictwo, bu dżet państwa poprzez podatki, są więc bar dziej ekologiczne. Nie czekajmy zatem na działania rządu ani innych sił, sami spraw my, aby konsumenci częściej wybierali na sze sklepiki, dajmy im to, co najlepsze, rozmawiajmy z nimi na ten temat. Edukuj my naszych klientów w zakresie zdrowego żywienia, pokażmy im, dlaczego naturalna i r zemieślnicza żywność ma przewagę nad przemysłową. Bawmy się ofertą, wchodź my w interakcje z klientami. Wykorzystuj my swoje social media do informowania o nowych produktach i aktualnej ofercie. Niech wysoka jakość będzie wyznacznikiem sklepów, rzemieślniczych piekarni, kawiarni i lodziarni. Polacy zasługują na najwyższą jakość żywności, a mogą ją dostać właśnie od nas!


Zapraszam do dołączenia do Stowarzyszenia „Rzemieślnik” zrzeszamy firmy niezależne. kontakt@rzemieslnik.org www.rzemieslnik.org Tradycyjne zapraszam do kontaktu i zadawania pytań poprzez mail do redakcji oraz do mnie: mistrzbranzy@pl kontakt@help4bakery.pl Mirosław Kurek – właściciel firmy consultingowej Help4Bakery, prezes Stowarzyszenia „Rzemieślnik”
Zapraszamy na webinaria prowadzone przez ekspertów CSB-System. Szczegóły na www.csb.com/pl
reklama
Specjalistyczne procesy branżowe, integracja maszyn i urządzeń, zarządzanie sklepami firmowymi, śledzenie pochodzenia, zarządzanie jakością i wiele więcej. CSB-System jest oprogramowaniem do zarządzania przedsiębiorstwem w branży piekarskiej i cukierniczej. Jest kompleksowym rozwiązaniem obejmującym ERP, FACTORY ERP i MES. Zawiera również standardy najlepszych praktyk.
Jeśli chcesz dowiedzieć się, dlaczego wiodące przedsiębiorstwa stawiają na CSB, zachęcamy do kontaktu.


Profesjonalna i miła obsługa jest jednym z najważniejszych czynników składających się na popularność sklepu. Współcześni klienci idą do niego nie tylko po zakupy – oczekują czegoś więcej. Przychodzą z szeregiem życzeń, które sprzedawca powinien spełnić.

Każda osoba odwiedzająca sklep zachowuje się inaczej. W dużej mierze wpływają na to indywidualne cechy charakteru. Specjaliści wyróżniają osiem podstawowych typów klientów: oglądający, niezdecydowany, zdecydowany, mil czek, gaduła, mądrala, wybredny, nieufny. Każdy z nich oczekuje innego podejścia. Zasadniczo jednak wy magania klientów wobec sklepów są zbieżne. Placówki handlo we najczęściej nie spełniają ich oczekiwań, spośród najczęściej wymienianych postulatów aż trzy dotyczą obsługi. W dobie popandemicznych czasów, z roszczeniowym personelem, brakiem wyspecjalizowanej kadry, w erze zawirowań gospodar czych spowodowanych wojną na wschodzie, wysokimi cenami pracownika, energii i świadczeń, warto zainteresować się kon cepcją samoobsługowego kiosku. Pomysł tego rodzaju piekarni sprawdza się z powodzeniem u naszych zachodnich sąsiadów. Jak się okazuje, takie lokale z ograniczonym menu cieszą się niebywałą popularnością. Mają przystępne ceny – także dla ob cokrajowców – i oferują szybkie przekąski w niestandardowych godzinach. Samoobsługa kojarzy się nam ewidentnie z hasłem „Mniej kolejek, szybszy zakup”.
Co jeszcze mają do zaoferowania te małe punkty piekarniczo -gastronomiczne, co odróżnia je od standardowych rozwiązań? Kioski pozwalają klientom na samodzielne zamawianie i opłacanie posiłków, co stanowi znakomitą alternatywę dla obsługi. Możemy

generować sprzedaż w dni wolne od handlu, na przykład w świę ta, w 24-godzinnym trybie, w godzinach zamknięcia lokali z ob sługą. Koncepcja ta świetnie sprawdzi się również w godzinach gastronomicznego szczytu. W czasie przerwy śniadaniowej czy lunchu, przy dużym natężeniu ruchu klienci zniechęceni kolejką przy kasie nie zrezygnują z zakupu. Powinny to być punkty, w których można szybko zjeść zdrową przekąskę. Takie piekarnie mogą stanowić realną alternatywę dla fast foodów, sprawdzą się również na lotniskach, w parkach czy przy szkołach. Biorąc pod uwagę dwa najważniej sze czynniki decydujące o wyborze miejsca, do którego de facto się udamy, strzałem w dziesiątkę jest właśnie takie rozwiązanie. Jednak że oprócz czasu ogromne znacze nie mają również jakość i różnorod ność asortymentu. Dlatego też taki mały punkt samoobsługowy będzie świetną alternatywą dla tradycyj nej sprzedaży, ale nie powinien jej zastąpić.


W tradycyjnej piekarni czy cukierni oprócz dużo większych możliwości ekspozycji, szerokości i głębokości asortymentu, mamy jeszcze czyn nik ludzki w postaci personelu. Do brze wyszkolona ekspedientka to dodatkowe narzędzie sprzedaży. Na wagę złota jest zwłaszcza taki pracownik, który potrafi uważnie słuchać klienta i aktywnie mu do radzać. Idealny ekspedient każde
mu klientowi daje poczucie, że został profesjonalnie obsłużony. Mało kto zda je sobie sprawę z tego, jak ważny dla budowania wizerunku sklepu jest spo sób, w jaki sprzedawca wita kupujące go. Obowiązuje tutaj tzw. „reguła 20” pierwszych 20 słów, gestów, sekund. Na ich podstawie kupujący wyrabia so bie opinię o poziomie obsługi.

Wiele osób wybiera małe lokalne skle py właśnie ze względu na „panią za ladą”, która się uśmiechnie, doradzi, podpowie… Przy okazji jest to forma budowania relacji z klientem, związy wania go z marką.
Prawdziwa relacja z klientem potrzeb na jest do uzyskania informacji, któ re przydadzą się w trakcie oferowania konkretnej grupy produktów. Jednej osobie polecimy nowości, innej wypieki na bazie szczególnej mieszanki przy praw, takie, które od razu przypadną jej do gustu, a jeszcze innej coś z asor tymentu dla diabetyków. Taka przyja cielska postawa sprzedawcy pozwoli dopytać o rogalik do kawy, zaproponować sok do kanapki. Tym samym sprawi, że klient po czuje się dopieszczony, a nasz biznes odpowiednio zaopiekowany. Warto obserwować rynek, wciąż zmieniające się możliwości. Roz ważyć, w jakim kierunku rozwijać firmę. Czy na przykład prze strzeń jest wystarczająca na decyzję o pełnowymiarowym sklepie piekarniczym, cukierni, kawiarni… czy akurat w tej lokalizacji nie postawić samoobsługowego kiosku handlowego. Wszystko zale ży od naszych możliwości finansowych, logistycznych, potencjału rynku i dostępności pracownika.
22-25 paź Dz iernika pO 3-letniej przerwie spOwODOwanej pan D e mią ODBy ły się targi sÜ DBack w s t uttgarcie. a k tualnie tO je D n a z największych imprez wystawienniczych związanych z B r anżą piekarniczą w e u rO pie. w Os tatnich latach targi te ewalu Owały, stając się wy Da rzeniem, które wyznacza kierunek rOz wOj u O r az jest źró D ł em inspiracji D l a B r anży.
 Tomasz Guderski, Geth
Tomasz Guderski, Geth



Polski akcent Łącznie 18% odwiedzających przyjechało z zagranicy (spoza krajów DACH), w tym z Polski. Pozytywny jest fakt, że liczba polskich klientów wciąż rośnie. Producenci pieczywa z naszego kraju na tle swoich kolegów z Europy Zachodniej prezentują się bardzo korzystnie. Komplementowa na jest dynamika rozwoju naszego sektora piekarskiego oraz inwestycje w nowoczesne wyposażenie czy ciekawe zmiany organizacyjne. Otwar tość piekarzy na wykorzystanie nowoczesnych rozwiązań z zakresu od zysku energii czy stosowanie zrobotyzowanej produkcji dyskutowane są w kręgach najznamienitszych specjalistów.
WystaWc y Wystawcy przywieźli wiele nowości, ze względu na pandemiczną przerwę w targach miały ono dużo czasu „na dojrzewanie”. Znacząco podniosło to prestiż wydarzenia. SÜDBACK zawsze przynosi ożywczy sygnał dla branży, a tego potrzebuje współczesne rzemiosło piekarskie.
obaW y Organizatorom i wystawcom towarzyszyło wiele obaw. Po pierwsze, od paru lat wystawcy odnotowywali mniejsze zainteresowanie uczestnictwem
w tego typu wydarzeniach. Powodem mogły być łatwa dostęp ność informacji przez internet czy bogate formy multimedialne. Po drugie, obawiano się, czy niemal 3-letnia przerwa spowodowana pandemią nie wpłynie negatywnie na mobilizację do przyjazdu, często z odległych stron Europy. I po trzecie, bodaj najważniejsze, zastanawiano się, czy globalny kryzys gospodarczy, wysoka inflacja i rosnące ceny energii nie spowodują wyhamowania inwestycji. Sytuacja wszystkich zaskoczyła, frekwencja była bardzo obie cująca, targi odwiedziło prawie 36 000 osób. Przez cztery dni 5 hal wypełniał nie tylko ujmujący zapach chleba, ale i tłumy zwiedzających. Najbardziej zaskoczył pierwszy dzień targowy, w k tórym frekwencja przewyższyła liczbę gości notowanych tego dnia w ostatnich latach.
Uśmiechy na twarzach wystawców i zwiedzających pozwoliły choć na chwilę zapomnieć, że zbliża się kryzys. To świetny znak – SÜDBACK ma pozytywny wpływ na branżę. Obsługa stoisk, przedstawiciele firm mieli ręce pełne pracy, targi przerosły ich oczekiwania. Zainteresowanie ze strony odwiedzających, zamó wienia uzupełniające i rozmowy dają powody, by spodziewać się tylko dobrych rzeczy.
Prowadzone przez uczestników dyskusje pokazują główne obszary zainteresowań. Są nimi przede wszystkim:
odzysk energii w piekarni każdej wielkości; rozwiązania technologiczne, które pozwalają na ograniczanie środków wspomagających procesy wypiekowe; technologia wydłużonej fermentacji nie tylko w aspekcie po prawy jakości produktu, ale też jako korzystna zmiana orga nizacji pracy nocnej; zakup urządzeń zrobotyzowanych, mogących zastąpić człowieka w najbardziej pracochłonnych obszarach nie tylko w dużych, ale także w małych zakładach rzemieślniczych.



s tatystyka inWe stycji Jeden z organizatorów targów podkreślił „bardzo wysoką jakość gości”. Pomimo złożonych wyzwań stojących przed branżą klienci przyjechali na SÜDBACK dlatego, że chcą inwestować. 69% odwie dzających potwierdziło, że bardziej lub mniej aktywnie uczestniczy w decyzjach zakupowych oraz dotyczących zaopatrzenia w firmie, w tym 23% dokonuje transakcji. Około 1/3 zdecydowanie chce doko nać zakupu lub zainwestować, 46% bierze pod uwagę taką ewentual ność. Co trzeci odwiedzający chce zainwestować w ciągu najbliższych 6 miesięcy – 30% z nich wskazało kwotę większą niż 50 000 euro. SÜDBACK dobitnie potwierdziły swoją rolę w branży piekarniczej i cukierniczej. Pomimo wielu wyzwań odwiedzający przybyli na targi, bo chcą doskonalić metody produkcji poprzez zakup no wych maszyn i technologii. Targi zarysowały perspektywy bran ży i nadały kierunek rozwoju na kolejne lata. Następna edycja SÜDBACK odbędzie się 26-29 października 2024 roku.


Ubijaczki planetarne UC z automatycznym lub manualnym podnoszeniem kotła firmy IBIS to nieodzowny element każdej cukierni. Zostały zaprojektowane w taki sposób, aby zapewnić maksymalną wydajność i długotrwałe użytkowanie przy minimalnym wkładzie w ich utrzymanie.

lu K sus niejedno M a i M i ę. Może dotyczyć zarówno ciaste K , ja K i sa M ochodów, zate M dlaczego by tych produ K tów nie połączyć?
Właściciel DESEO Łukasz Smoliński nie boi się takich połączeń. 5 listopada w Warszawie ruszył nowy koncept, który współtwo rzy jego butikowa cukiernia. Tym razem to inicjatywa unikato wa w skali nie tylko Polski, ale i całego świata. Kawiarnia jest wspólną kooperatywą DESEO i marki samochodowej – Volvo Car Warszawa. Nic więc dziwnego, że część wystroju kawiarni stanowi samochód. W witrynie królują jednak znane wielbicie lom warszawskiej cukierni ciastka oraz lody, praliny i czekolady marki DESEO. Lokal jest integralną częścią salonu przy ulicy Marszałkowskiej 89. n



Maszyny do kremów firmy IBIS to idealne urządzenia do wszechstronnej pro dukcji. Umożliwiają jed noczesne grzanie i mieszanie produktów. Te multifunkcjonalne urzą dzenia do zaparzania, go towania, topienia i praże nia doskonałe dla Twojej cukierni lub piekarni.

Fani K atowic K i ego Ka Fe ja, znanego z o Fe rty śniadaniowej, M ogą cieszyć się również
eleganc K i M i d esera M i – w łaściciele otwarli Ko lejny lo K a l. t y M raze M dedy Kowany słod Kościo M .
I Alicji w krainie czarów. Właśnie ten motyw na tyle spodobał się Kalinie Korus, właścicielce, że postanowiła tchnąć du cha tajemnicy i niezwy kłości w w ystrój wnętrza nowego lokalu mieszczącego się przy ulicy 3 Maja 2. W witrynie zobaczymy francuskie specja ły z croissantami na czele, a także praliny i monoporcje. Więcej infor macji w kolejnym wydaniu „MB”. n

















To była nie T y lko wyrównana walka, ale przede wszys Tk im pokaz niezwykłych Ta lenTów i m ożliwości jednego niezwykłego składnika – czekolady.

31 października w Paryżu po kilku latach oczekiwania ogłoszono kolejnego zdobywcę tytułu World Chocolate Master. Został nim Lluc Crusellas z Hiszpanii, który po konał rywali, gromadząc 434 punkty w siedmiu zadaniach. Obok niego na podium stanęli Antoine Carreric z Francji oraz Grek Nico las Nikolakopoulos, którzy jako jedyni zdołali przekroczyć barierę 400 punktów. Nasz reprezentant – Igor Zaritskiy, szef Warsaw Academy of Pastry Arts – ostatecznie uplasował się na 10. miej scu, serdecznie gratulujemy! Zwycięstwo Crusellasa to sytuacja bezprecedensowa. Po raz pierw szy w historii tego konkursu, w ciągu 8. edycji, czyli 17 lat trwa nia WCM, hiszpański pastry chef zdobył najwyższe miejsce na podium. Do tej pory żadnemu reprezentantowi narodowemu nie



Hipperealistyczny słoń, ważący ponad 170 kg słoń symbolizuje walkę o przetrwanie w obliczu groźnych zmian klimatycznych zdobywcy 1. miejsca – Lluc'a Crusellas (Hiszpania)

Jak sam przyznaje tym, co go motywowało była myśl, że w jego ojczyźnie toczy się wojna, gdzie ludzie giną w strasznej walce. Jego walka w finale miała więc symboliczny wymiar, co wyraził wygłaszając przed jury swoją „power speech” udało się stanąć na podium. Przy okazji ustanowił też inny rekord – jest najmłodszym laureatem tytułu World Chocolate Masters. Wreszcie, Hiszpan został też obsypany nagrodami specjalnymi, w tym: nagrodą publiczności, prasową, za najlepszą prezentację w kategorii #Wow oraz #Design. Każda z jego prac bezsprzecznie wzbudzała zachwyt jury. Naj większe emocje, także wśród zwiedzających targi Salon du Cho colat, wywołała jego witryna, w której stanął ogromnej wielkości hiperrealistyczny słoń. Witryny, w których zostały umieszczone rzeźby, wzbudzały nie tylko podziw, ale i… stanowiły problem. Duża część uległa znisz czeniu, a niektórym nie powiodło się złożenie w całość, co nie pozwoliło dotrzeć na podium, np. Jiro Tanace, który w każdej innej kategorii typowany był na laureata. n




Jedyna kobieta w finale, Włoszka Anna Gerasi, zdobyła nagrodę za najbardziej zrównoważone wykonanie



Czekoaldowa rzeźba i witryna Igora Zaritskyi'ego zachwyciła jury, co pozwoliło mu dostać się do dziesiątki superfinalistów
Czekoladowa rzeźba i witryna laureata 2. miejsca – Antoine'a Carreric (Francja)
Jurorem z Polski po raz drugi został mianowany Krzysztof Ilnicki. Na zdjęciu z szefem Akademii
Czekolady – Kamilem Szulcem, który był supporterem Igora Zaritskyi'ego
Czekoladowa rzeźba i witryna laureata 3. miejsca – Nicolasa Nikolakopoulosa
Przed ogłoszeniem wyników przewodniczący jury, Amaury Guichon, podsumował wystąpienie każdego z 10 finalistów
Top 10 world Chocolate Masters




Lluc Crusellas (Hiszpania)


Antoine Carreric (Francja)
Nicolas Nikolakopoulos (Grecja)
Anna Gerasi (Włochy)
Christophe Rull (USA)
Dongsuk Kim (Korea)
Jiro Tanaka (Japonia)
Togo Matsuda (Belgia)
Jacky Lung (Chiny)
Igor Zaritskyi (Polska)
Puratos jest międzynarodową grupą oferującą kompletną ofertę innowacyjnych produktów oraz wiedzę ekspercką dla rzemiosła, przemysłu, sieci handlowych, sektora HoRe Ca w branży piekarniczej, cukierniczej i pro dukcji wyrobów czekoladowych. Naszym celem jest rozwój planety dzięki tworzeniu innowacyjnych rozwiązań żywnościowych dla zdrowia i dobrego samopoczucia ludzi na całym świecie. Więcej informacji dostępnych na: www.puratos.pl
pi erwsza na ryn K u m ieszan K a do wypie K u w egańs K i ch ciast drożdżowych i pącz Ków j est już dostępna. to K rapfen Ko nzentrat Vegan od pu ratos.
W ostatnim czasie obserwujemy znaczny wzrost zainteresowania dietą roślinną. Z bada nia Taste Tomorrow 2021 przeprowadzonego przez firmę Puratos wynika, że 57% polskich konsumentów uważa żywność na bazie składników roślinnych za zdrowszą niż ta bazująca na produktach pochodzenia zwierzęcego. Na przestrzeni ostatnich 3 lat liczba ta zwiększyła się aż o 25 punktów procentowych, co potwierdza, że weganizm nie jest tylko chwilowym trendem. Jednocześnie z badań wynika, że dobry smak to najważniejsze kryterium wyboru wypieków cukierniczych, co dotychczas stawiało miłośników kuchni roślinnej przed trudną decyzją.
– Wegetarianizm i weganizm jeszcze kilka lat temu traktowane były w Polsce jako przejaw ekscentryczności. Dziś to już powszechne zjawisko, a kuchnia roślinna stała się częścią jadłospisu Polaków. Wraz z rosnącą liczbą osób niejedzących mięsa i produktów pochodzenia zwierzęcego wzrósł też popyt na roślinne produkty. Do tychczas konsumenci sięgający po wypieki wegańskie musieli iść na kompromis względem smaku. Roślinne wypieki stworzone na bazie Krapfenkonzentrat Vegan smakują tak samo dobrze jak ich klasyczne wersje. To dobra wiadomość dla branży cukierniczej, ponieważ nowy produkt od Puratos pozwala dotrzeć do konsumen tów szukających zdrowszych i lepszych dla planety alternatyw bez utraty walorów smakowych i t ym samym wyróżnić się na tle konkurencji – informuje Dominika Nowakowska, product manager Puratos Polska.
Wypieki na bazie mieszanki Krapfenkonzentrat Vegan bazują w 100% na skład nikach roślinnych. Charakteryzują się długą trwałością i dobrym smakiem, dzięki czemu są odpowiednie nie tylko dla miłośników kuchni roślinnej.

Zaletą mieszanki jest możliwość zastosowania do całej gamy ciast drożdżowych: pączków, drożdżówek, babek czy chałek. Jej użycie gwarantuje stabilność procesu produkcyjnego. Sprawdza się zarówno w obróbce ręcznej, jak i mechanicznej. Wypieki na jej bazie mogą być produkowane metodą bezpośrednią i odroczonego rozrostu.
W ofercie firmy Puratos poza mieszanką Krapfenkonzentrat Vegan znajdują się też kompletne rozwiązania do tworzenia wypieków piekarskich i cukierniczych odpo wiednich dla wegan. n

t ysiące zwiedzających, setki rozmów biznesowych, prelekcje i panele dyskusyjne, do tego konkursy, pokazy i warsztaty oraz – tradycyjne z łote m e dale g rupy mtp – wyróżniające najlepsze produkty. po trudnych latach tegoroczna polagra odzyskała dawny blask. to n ie koniec dobrych wiadomości. w przyszłym roku targi czeka poważna zmiana.
Na trzy dni (od 26 do 28 września 2022 r.) Międzynarodowe Targi Poznańskie zmieniły się w centrum branży spożywczej i sektora HoRe Ca. Czego poszukiwali zwiedzający? Przede wszystkim optymalnych rozwiązań, urzą dzeń i produktów, które pozwalają rozwijać działalność, ale też przetrwać trudne czasy.
Zbliża się kry Z ys – Na naszych oczach sprawdza się sta re chińskie przekleństwo: obyś żył w ciekawych czasach. W obliczu kryzysu jedni mogą się załamać, inni dostrzegą w nim szansę. POLAGRA jest po to, by przedsię biorcy znaleźli nowe rozwiązania i wyszli z kryzysu wzmocnieni. Wówczas za kilka lat staniemy się silniejsi i będziemy od nosić sukcesy – mówił podczas otwarciu targów prezes zarządu Grupy MTP Tomasz Kobierski.
W ostatnich miesiącach słowo „kryzys” w kontekście branży spożywczej pojawia się nad wyraz często. Jak zaznaczał, dlate go warto spotkać się na targach, żeby się poznać i wspólnie poszukiwać rozwiązań, również technologicznych.
s tała i pewna jakość Właśnie takie rozwiązania i technologie oferowało ponad 140 wystawców, których stoiska zostały zlokalizowane w strefach Food, Foodtech i Horeca. Zaprezentowano na nich setki narzędzi, maszyn i technologii. To na nich rozmawiano też z aktualnymi i potencjalnymi klientami. Kilkadziesiąt produktów zostało – tradycyj nie już – nagrodzonych Złotym Medalem Grupy MTP. Sąd konkursowy zdecydował o przyznaniu 21 medali dla produktów prezentowanych w Salonie Food oraz 9 w Salonie Foodtech. Przyznano również dodat kowy Złoty Medal Potwierdzona Jakość. Osobnego wyboru dokonali też konsumenci. Laureatów konkursu Złoty Medal Wybór Konsumentów poznaliśmy pierwszego dnia POLAGRY, a przedstawiciele zwycięzców odebrali statuetki i dyplomy. Symbolem jakości produktów spożywczych pomagającym konsumentom w dokonaniu wyboru jest też znak „Poznaj Dobrą Żyw ność”, nadawany przez Ministra Rolnictwa i Rozwoju Wsi. Uroczyste wręczenie tego wy różnienia odbyło się pierwszego dnia targów. W gali zorganizowanej przez resort rolnictwa





uczestniczyli przedstawiciele zarządu Grupy MTP oraz – w roli gospodarza – sekretarz stanu w Ministerstwie Rolnictwa i Rozwoju Wsi Rafał Romanowski. Wiceminister gościł na POLAGRZE w sumie przez 2 dni. Brał m.in. udział w ceremonii otwarcia, poprze dzonej konferencją prasową. Ta objęła tematykę systemu produkcji polskiej żywności, który należy do najnowocześniejszych w Europie. Jak zwrócili uwagę jej uczestnicy, przez lata Polska bardzo dobrze wykorzy stała możliwości rozwoju, choćby te wynikające z członkostwa w Unii Europejskiej.
w posZu kiwaniu roZ wią Z ań
Wiceminister otworzył też – razem z przedstawicielami zarządu Grupy MTP – kon gres Polagra Export Meeting, na którym poruszono zagadnienia eksportu polskiej żywności na rynki zagraniczne. Wraz z prezesem Tomaszem Kobierskim i ekspertami zaproszonymi przez Związek Pol skie Mięso był też gościem konferencji „Fuel for Life”. Jej tematyka objęła m.in. ograni czenia, bariery w hodowli i eksporcie mięsa oraz rozwiązania skrojone na trudne czasy.
Nic dziwnego, że konferencja „Branża spo żywcza. Strategie na trudne i niepewne czasy” organizowana – po raz pierwszy na targach POLAGRA – przez redakcję „Wiadomości Handlowych” również przyciągnęła publiczność. Producenci żywności, przedsta wiciele organizacji branży spożywczej i sek tora mlecznego rozmawiali na niej o możliwych scenariuszach na kolejne miesiące i sposobach radzenia sobie w dobie wojny, kryzysu energetycznego i surowcowego. Nowością była debata i prelekcje dotyczą ce systemu kaucyjnego i rozszerzonej odpowiedzialności producentów. Ten temat poruszono też podczas eksperckiego, praw
niczego szkolenia obejmującego zagadnie nia znakowania opakowań. Wydarzenie to także cieszyło się uznaniem zwiedzających.
Mistr Zowie (nie tylko) kuchni
Po 3 latach przerwy wrócił finał Kulinarnego Pucharu Polski. Właścicieli restauracji, lokali gastronomicznych, lodziarni, cukierni i pracowników sektora HoReCa nagrodzono na scenie POLAGRY podczas wręczenia nagród w ogólnopolskim plebiscycie „Mistrzowie Sma ku” organizowanym przez Polska Press Grupa. Szefowie kuchni uczestniczyli w warsztatach Chefs Academy, a wszyscy chętni mogli przyjrzeć się pokazowi gotowania w wykonaniu Wojciecha Harapkiewicza i Joanny Brodzik. Dwanaścioro uczestników przez 2 dni ry walizowało w Ogólnopolskim Konkursie dla Piekarzy Master Baker, a piekarze dzieli się wiedzą również podczas Forum Piekarskie go Zdrowe Pieczywo.




Z M iany, ZM iany, ZM iany… Prace do przyszłorocznej edycji targów POLAGRA już się zaczęły. Czekają ją istot
ne zmiany. Przede wszystkim nastąpi sil ny zwrot w stronę żywności ekologicznej i organicznej. – Mamy świadomość nadal rosnącego potencjału tego segmentu rynku spożywczego i wiemy, jak go wykorzystać – zapowiada Dariusz Wawrzyniak, dyrektor grupy produktów Grupy MTP. – Nie zapomi namy oczywiście o naszych tegorocznych wystawcach i zwiedzających. Rozmowy z nimi, jakie przeprowadziliśmy podczas targów, były bardzo pouczające, a przede wszystkim owocne. Już dziś zapraszamy ich, potencjalnych klientów i wszystkich zwiedzających na wrzesień 2023 – podsumowuje.
Zmiana numer dwa ma charakter orga nizacyjny, ale przyniesie też korzyści dla potencjalnych wystawców. Przyszłorocz ną POLAGRĘ zaplanowano na 27-29 września. Odbędzie się więc w środę, czwartek i piątek. Ostatni dzień będzie jednocześnie pierwszym Smaków Regionów.
Więcej informacji: www.polagra.pl. n
Tuzy francuskiej gastronomii wydały w tym samym czasie książki wspomnienia, które przybliżają nam ich drogę do osiągnięcia cukierniczego kunsztu. 6 października Toutes les saveurs de la vie (Wszystkie smaki życia) pokazał Pierre Hermé. Publikacja poświęcona została jego ży ciu. Książka powstała we współpracy z dziennikarką kulinarną Catherine Roig. Cukiernik po raz pierwszy zdecydował się na zwierzenia, opowiada o początkach i wyzwaniach swojej pasji, o pragnieniu wiedzy, które zapro wadziło go do wielu zakątków świata w poszukiwaniu najlep szych kaw, czekolad, wanilii, do spotkań z mistrzami cukierniczego rzemiosła, którzy mieli wpływ na jego drogę zawodową.
Pierre Hermé, Touteslessa veursdelavie,wydawnictwo Buchet-Chastel, 309 stron, premiera 6 października 2022 r.
Do grona autorek ku linarnych nowości do łączyła również Magdalena Tomaszewska-Bolałek z kolejną pozycją na temat kuch ni skandynawskiej. Pod koniec października badaczka kultury kulinarnej rozpoczęła promocję Tradycji kulinarnych Norwe gii. Smakosze – jak przekonuje Magdalena Tomaszewska-Bolałek – znają z pewnością trend new nordic cuisine, czyli serwowania potraw jak najmniej przetworzonych, nieskomplikowanych, ba zujących na tradycji, estetycznie, a nawet wyrafinowanie po danych, w czym specjalizuje się np. wielokrotnie wyróżniana nagrodami duńska restauracja Noma. Magdalena Tomaszewska-Bolałek, Tradycjekulinarne Norwegii, wydawnictwo Hanami, 240 stron, premiera 27 października 2022 r.
Drugi ze znanych mi strzów francuskiej kuchni – Alain Ducasse – również wydał książkę biograficzną, której tytuł – Uneviedegoûtsetdepassions – możemy przetłumaczyć jako życie pełne smaków i pasji. Ducasse jest cukiernikiem, restauratorem, nauczycielem i założycielem szkół kulinarnych. To nie jest – jak podaje nota wydawcy – zbiór wspomnień, ale sposób podziele nia się emocjami, jakie wiążą się z jedzeniem posiłków, z przygotowaniem dań, z odkrywaniem i delektowaniem się smakami.




Alain Ducasse, Uneviedegoûtsetdepassions,wydawnictwo JC Lattès, 240 stron, premiera 12 października 2022 r.

Recepturami na
ciastka dzielą się też wła ściciele presti żowej i kultowej cukierni butikowej Lu kullus w Warszawie. Na 500 stronach publikacji znajdziemy 75 przepisów, 200 receptur na półpro- dukty, i 400 haseł z teorii i ciekawostek dotyczą cych ciastkarstwa. Książka zawiera też słodkie mapy Warszawy i Paryża. Jak mówią autorzyAlbert Ju dycki oraz Jacek Malarski:
To książka, o jakiej sami marzyliśmy, kiedy zaczynaliśmy pracę. Napisana z myślą o cukierniczkach i cukiernikach oraz wszystkich, którzy chcieliby nimi zostać. To nasza próba odnalezienia języka rzemiosła i nakreślenia mapy najprzyjemniejszego zawodu świata. Albert Judycki, Jacek Malarski, Noweciastkarstwo , 500 stron, premiera 19 listopada 2022 r.
Swoją pasją i miłością do pierników dzieli się też ich niekwestio nowana kró lowa – Iga Sarzyńska na łamach świeżo wydanego autorskiego albumu. Mojepierniki to nie tylko skarbnica wiedzy o magicznym piernikowym cieście i jego składnikach, ale również zbiór receptur i tajników cukierniczej dekoracji. Na ponad 200 stronach znalazły się przepisy na kunsztow ne zdobienia pierników artystycznych: toruńskich kamieniczek, świątecznych śnieżynek czy koników na biegunach, ale też na przysmaki piernikowe: markizy, chlebki, pierniczki migdałowe, żytnie, a nawet na piernik w s łoiku czy syrop piernikowy.
Iga Sarzyńska-Komorowska, Mojepierniki,200 stron, premiera 4 listopada 2022 r.
Francus K i e legendy cu K i ernictwa, K rólowa pierni Ków, badacz K a dziejów K u linarnych oraz K u ltowa cu K i ernia buti Kowa – jesienią możemy cieszyć się prawdziwym wysypem świetnych pozycji K s iąż Kow ych!
To nie jes T kolejna książka o czekoladzie
W Chocolatier’s Kitchen 7 szefów Callebaut odpowiada na pytania, które otrzymywali na przestrzeni lat od cukierników i chocolatierów z całego świata, pragnących otworzyć własny biznes. Mimo iż książka zawiera aż 273 receptury, jej cel jest inny niż jakiejkolwiek książki z przepisami: ma wspierać rzemieślników w rozwijaniu ich ambicji.
15 lat po su Kc esie Fine ChoColates zespół sze Fów c a llebaut wraz z belgijs K i m wydawcą l a nnoo prezentują nową K s iąż K ę o c ze Ko ladzie. w y danie ChoColatier’s KitCh en o Fe ruje przedsiębiorczym cze Ko ladni Ko m pragmatyczne narzędzia do pomyślnego rozpoczęcia i rozwoju ich działalności.
Chocolatier’s Kitchen przedstawia system biorący pod uwagę przydatność do spożycia produktów, który pomo że nowym przedsiębiorcom zbudować optymalny asortyment i podzielić go na kategorie produktów konfekcyjnych o krótkim (2 t ygodnie), średnim (8 ty godni) i długim (6 miesięcy) okresie przydatności. Książka inspiruje też re cepturami z wykorzystaniem 5 kolorów czekolad Callebaut (ciemnej, mlecznej, białej, złotej i ruby) w postaci zachwy cających połączeń smaków, nowych kształtów czy prezentacji. – Każdy początkujący przedsiębiorca zmaga się z dylematem estymacji sprzedaży swoich produktów wobec terminu ich przydatności do spoży cia. Dzięki zbalansowaniu oferty pro duktami zarówno świeżymi, jak i tymi o długim okresie przydatności nowicjusze mogą lepiej planować produkcję i sprzedaż – tłumaczy Minette Smith, szef kreatywny Callebaut. – Wielu funkcjonujących czekoladników rozwija sprzedaż za pośrednictwem kanałów internetowych. Jednak potrzebują do tego produktów, które zachowają świeżość podczas wysyłki. Receptury o średnim i długim czasie przydatności do spożycia z tej książki zapewnią czekoladnikom szansę na rozwój na kolejnych rynkach, bez re zygnacji z wybitnej jakości – dodaje.
The Chocolatier’s kitchen, język publikacji: angielski, francuski, holenderski, cena: 120 euro Autorzy: Davide Comaschi – world chocolate master & globalny ambasador Akademii Czekolady Philippe Vancayseele – szef Akademii Czekolady, Kanada Mark Tilling – szef Akademii Czekolady, UK Clare England – szef Akademii Czekolady, UK Beverley Dunkley – były szef Akademii Czekolady, UK
Ciro Fraddanno – szef Akademii Czekolady, Włochy Ryan Stevenson – executive pastry chef, Australia
z drugą książką pragniemy przedstawić czytelnikom poradnik, który zaoferuje przegląd wszystkich zagadnień i decyzji, z jakimi przyjdzie im się zmierzyć. Od biznesplanu po wybór nazwy fir my, poszukiwanie swojej niszy, zapla nowanie działań marketingowych, wy bór odpowiedniego kanału sprzedaży oraz niezbędnego sprzętu – podkreśla Minette Smith.
NastęPN y rozdział w uda N e j serii Publikacji Dzięki obu książkom szefowie Callebaut i wydawca Lannoo tworzą kolejny rozdział w tradycji wydawania warto ściowych publikacji dla rzemieślników. – Nasza współpraca z szefem i doradcą technologicznym Callebaut Jean-Pierre’em Wybauw między późnymi latami 80 a 2000 zaowocowała serią 4 wspa niałych publikacji Fine Chocolates, któ re zyskały globalny sukces – opowiada dyrektor Lannoo Johan Ghysels. Książki zwyciężyły w plebiscycie World Food Media Awards – Gourmand World Cookbook Awards, jako najlepsza, sprzedana w 50 000 kopii publikacja o czekoladzie. Stały się kultową pozycją wśród czekoladników na całym świecie i są używane do dziś.

Pierwsza z dwóch książek Szefowie Callebaut nie spoczywają na laurach. Chocolatier’s Kit chen to pierwsza z dwóch pozycji, które pomogą wspierać po wstający i rozwijający się biznes. Premiera drugiej planowana jest na rok 2023. Odpowie ona na wiele pytań, jakie mogą stawiać sobie właściciele nowych i rozwijających się biznesów. – Wraz
– Nadszedł właściwy moment, aby od nowić naszą współpracę z nową generacją szefów Callebaut. Świat się zmienił, podobnie jak biznesowe i kre atywne wyzwania następnej generacji. Ta książka rzuca nowe światło na to piękne rzemiosło dzięki najlepszym, belgijskim cze koladom – czemuś, z czego my, jako belgijski wydawca, możemy być tylko dumni. Chcemy po raz kolejny zainspirować rzemieślników na całym świecie – dodaje Johan Ghysels. Obie książki będą dostępne osobno, niebawem będzie można je kupić również w komplecie zatytułowanym The Chocolatier’s Toolbox
Misja Callebaut: rozwój! n
Master Baker to jedno z nie licznych wydarzeń dla piekarzy. W t ym wypadku do zmagań z w y piekami zaproszeni są nie tylko profesjo naliści, co czyni wydarzenie jeszcze cie kawszym. Organizatorem konkursu jest Ogólnopolskie Stowarzyszenie Przetwór ców i Producentów Produktów Ekologicz nych „Polska Ekologia”. W jury zasiedli: Czesław Meus, Katarzyna Mojzykiewicz, Piotr Kucharski, Łukasz Dobrowolski, Piotr Złociński oraz Piotr Połomski, który jest również jest koordynatorem i pomysłodaw cą wydarzenia. n






m i mo że sezon Lo dziarski został J uż ofic Ja Ln ie zamknięty, J e den z na J Ba rdzie J znanych i uta Le ntowanych Lo dziarzy w Po L sce nie zwa Ln ia tem Pa!
Tomasz Szypuła, właściciel rzemieślniczej Lodziarni pod Orzechem w Baborowie, ma na swoim koncie liczne wyróżnienia, w t ym również międzynarodowe. Niedawno podczas Forum Rozwoju Regionalnego na Politechnice Opolskiej odebrał odznakę honorową za zasługi dla rozwoju gospodarki Rzeczypospolitej Polskiej. Lodziarz jest też laureatem nagrody przyznawanej podczas ogólnopolskich targów Smaki Regionów w konkursie „Nasze Kulinarne Dziedzictwo – Smaki Regionów” (XXI edycja). Jego lody z dawnych lat otrzymały „Perłę”. Na spotkaniu Dziedzictwo Kulinarne Opolskie ich autor otrzymał także podziękowanie za wkład i zaangażowanie w promocję kulinarną województwa opolskiego. n
Paweł Tkaczuk (Pajda Manufaktura Chleba, Warszawa)
Karol Żuber (Na2 Piekarnia, Lublin)
Tatiana Iaremenko (Piekarnia Poolish, Wrocław)

Koła Gospodyń Wiejskich
Anna Cabaj (KGW U Tatara, Otfinów)
Marek Bobin (KGW Zgodni, Braniewo)
Ewa Niedźwiedź (KGW Na Fali, Dźwirzyno)
Wiktoria Suchenko (Zespół Szkół Gastronomicznych nr 1 w Krakowie)
Oliwia Zapisek (Zespół Szkół Centrum Kształcenia Rolniczego im. K Kluka w Rudce)
Wiktoria Kos (Zespół Szkół Zakładu Doskonalenia Zawodowego w Kielcach)
Anna Jakutajć-Wojtalik
Barbara Dumańska
Sylwia Kościelska
Jednym z ważnie Jszych wydarzeń towarzyszących targom Po L agra J e st konkurs m a ster Baker. w tym roku odBy ła się 3. edyc Ja Pi ekarskie J rywa Li zac J i .

16 października w w ęgierskiej gó rce odbyło się prawdziwe święto czekolady. d r zwi manufaktury b e skid c h ocolate otwarły się dla jej wielbicieli, natomiast w pobliskiej hali widowiskowej trwał festiwal czekolady z wystawcami z różnych zakątków po lski oraz częścią edukacyjną w postaci prelekcji.
Beskid Chocolate to jedna z nie licznych kraftowych marek na polskim rynku. W ciągu kilku lat udało się jej zaistnieć w szerszej świadomości, w związku z czym właściciele za częli myśleć o produkcji na większą skalę. To zadecydowało o przeniesieniu się do nowego budynku o łącznej powierzchni 1600 m2. W chwili obecnej zaadaptowano ok. 600 m2, na które składają się: część biurowa, część warsztatowa i sklep firmowy (150 m2) oraz część produkcyjna (300 m2). Remont trwał od stycznia 2022 r. aż do października.





– Od początku zdawałem sobie sprawę, że nie jestem w stanie sfinansować całej linii produkcyjnej, przeprowadzając równolegle remont kapitalny kupionej nieruchomości
– mówi Jan Woźniak i dodaje. – Co prawda starałem się o dofinansowanie ze środ ków UE, ale się nie udało. Musiałem więc poszukiwać rozwiązań budżetowych i kupiłem część sprzętu w Turcji. Producenta znalazłem w internecie, ale nie posiadał żadnych referencji z Polski ani z krajów sąsiednich. Najbliższa instalacja działała w jednym z krajów skandynawskich, więc tam zasięgnąłem opinii. Podjąłem ryzyko i kupiłem kilka urządzeń, młyn kulowy, tanki przechowalnicze. Sprzęt dotarł do mnie w ubiegłym roku, a testy rozpocząłem zimą br.
Jak podkreśla właściciel, nie jest to typo wy sprzęt do produkcji od ziarna do ta bliczki, dlatego niektóre problemy z tym związane musiał rozwiązać we własnym
zakresie, głównie etap przeniesienia cze kolady, pozostałości łuski kakaowej w gotowej czekoladzie oraz proces konszowania. Ostatecznie konsze zbudował sam, są one aktualnie w fazie testów i dalszych mody fikacji technicznych. Już na początku 2023 r. właściciele rozpoczynają drugi etap remontu związany z przystosowaniem budynku do celów pro dukcyjnych. Będzie ono dotyczyło przy gotowania magazynu wyrobów gotowych wraz z pakowalnią produktów i magazynu ziarna. Budynek zostanie przeprojektowa ny również pod kątem rozszerzenia strefy do zwiedzania w taki sposób, aby więcej pomieszczeń produkcyjnych można było udostępnić zwiedzającym. n




















